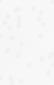

Christliche Bücher, Musik, Filme, Geschenke & Kalender






















SCM Verlag
SCM Hänssler
SCM R.Brockhaus







































SCM Verlag
SCM Hänssler
SCM R.Brockhaus
















in meinen drei Jahrzehnten im Verlagswesen ist mir aufgefallen, dass christliche Bücher sich vergleichsweise wenig mit dem Thema »Schöpfung« beschäftigen. Es gab natürlich Kinderbücher und Titel zu Debatten zur Schöpfung/Evolutions-Thematik, doch die Verantwortung, die Erde zu bebauen und zu bewahren, wurde selten thematisiert. Mögliche Gründe liegen in theologischen Diskussionen, eschatologischen Vorstellungen, politischen Vorbehalten und der Angst vor Ablenkung von Jesus Christus. Aber sollten nicht gerade wir Christen offensiv für die Bewahrung der Schöpfung eintreten?
Unsere SCM Verlagsgruppe hat deshalb gemeinsam mit Kirchenverbänden und freien Werken die »Initiative Schöpfung« ins Leben gerufen, um auf die Bedeutung der Bewahrung der Schöpfung hinzuweisen (www.initiative-schoepfung.net).
Wir bieten Publikationen und praktische wie lebensnahe Hilfen für jeden Einzelnen, aber auch Kirchen und Gemeinden an.
Diese Initiative ist Schwerpunkt unseres aktuellen Programms, aber natürlich haben wir noch weit mehr.
Viola Ramsden reflektiert in ihrem fesselnden Werk »Herzen ohne Mauer« das Leben der Christen vor und nach dem Zusammenbruch der DDR. Bestsellerautor John Mark Comer fordert mit seinem neuen



Buch »Vom Meister lernen« auf seine präzise Art heraus. Außerdem möchten wir auf die wunderschöne Ausgabe der Psalmen hinweisen, die von drei bekannten christlichen Influencerinnen gestaltet wurde und sicherlich viele Leserinnen und Leser ansprechen wird.
Für Liebhaber von Romanen empfehle ich besonders »In Zeiten der Freundschaft« von Cathy Gohlke, ein Werk, das zum Eintauchen in eine berührende Geschichte einlädt. Nicht zuletzt möchte ich auf »Der Tag, an dem der Sommer zu Ende ging« von Vivien Neufeld hinweisen. Als Ehefrau unseres Kollegen Harry Neufeld, der bei der Flutkatastrophe im Ahrtal tragischerweise seine Eltern und seinen Bruder verlor, hat sie ein Buch geschrieben, das weit über die Tragik der Ereignisse hinaus Hoffnung und Mut vermittelt.
Von leicht zugänglichen bis hin zu wissenschaftlichen Themen bieten wir Ihnen wieder einmal einen bunten Blumenstrauß an interessanten und inspirierenden Inhalten.
Herzlich, Ihr
Hans-Werner Durau
Verlagsleiter SCM Verlag




























































Das Thema Nachhaltigkeit und Bewahrung von Gottes Schöpfung geht uns alle an. Das zeigt auch Dörte Heyn mit diesem Buch. Es ist: Eine Einladung an alle, sich auf den Weg zu machen und wieder neu über Gottes wunderbare Schöpfung zu staunen. Ein bunter Werkzeugkasten voller Ideen, Experimente und Gedankenanstöße. Eine einmalige Entdeckungsreise zum Thema Nachhaltigkeit quer durchs Kirchenjahr. Ein Buch, das Kirche aus den angestaubten Bankreihen mitten hinein in die Natur holt.
Michaela Wölfle Lektorat Buch












Vereint? Gefühlt sind in unserem Land viele Brücken eingerissen oder in einem maroden Zustand. Viola Ramsden erzählt in ihrem Buch elf persönliche Geschichten aus unterschiedlichen Generationen mit verschiedenen christlichen Prägungen und ordnet sie ein. Was sie gemeinsam haben? Es sind ostdeutsche Geschichten, die ins Herz gehen und uns bewegen. Sie bewegen uns, aufeinander zuzugehen, uns im Herzen zu vereinen und wieder Brücken zu bauen.


Tabea Halbmeyer Lektorat Buch
















Wenn gute Gespräche entstehen, passiert etwas Besonderes: Man entdeckt neue Seiten aneinander, lacht miteinander, teilt Erinnerungen – Verbundenheit entsteht. Zum Glück muss man nicht mehr darauf warten, dass sich solche Momente zufällig ergeben. Die Fragebox »herzlich.ehrlich« bietet mit zwei Ausgaben jede Menge richtig guter Fragen, die gute Gespräche entfachen. Unbedingt ausprobieren!

Annegret Prause Programmleitung Geschenke & Kalender






Wer bei Reisen, auf Freizeiten, im Familienkreis oder in der Kleingruppe auf das gemeinsame Singen nicht verzichten möchte, dem sei das neue Liederbuch »10.000 Gründe« empfohlen. Das handliche und kompakte Liederbuch enthält mehr als 70 Lieder und deckt dabei ein breites stilistisches und inhaltliches Spektrum ab. Vom bekannten Choral über Klassiker der 90er-Jahre bis hin zu aktuellen Worship-Liedern ist für jeden musikalischen Geschmack etwas enthalten. Eine empfehlenswerte Liedsammlung für den Alltag!


Programmleitung
Bibel & Theologie





»Die Psalmen: Ein Buch voller Schönheit, Weisheit und Ho nung.« Die Psalmen zeigen, was Menschsein bedeutet. Sie sind authentischer Ausdruck von tiefster Wut wie von größter Freude und können uns daher Ermutigung und weiser Ratgeber sein. Dieses liebevoll gestaltete Co ee-Table-Book untermalt mit atmosphärischen Fotos und sanftem Design die wunderschöne Dichtkunst der Psalmen und gibt ihnen auf diese Weise Raum, um ihre Wirkung zu entfalten.


























GRETA WARTET AUF
WEIHNACHTEN –
WIE DER ADVENTSKRANZ
ERFUNDEN WURDE




Einen Adventskranz kennt jeder. Aber wo kommt er eigentlich her? Und was hat es mit den roten und weißen Kerzen auf sich? Dass Jesus das Licht der Welt ist, lernen die Kinder spielerisch im Adventsbuch zusammen mit Greta. In der Adventszeit wird mit den enthaltenen Vorlagen jeden Tag eine Adventskerze gebastelt. Mit tollen, stimmungsvollen Illustrationen der perfekte Begleiter für die Zeit bis Weihnachten.

 Anita Schalk Programmleitung Kinderbuch
Anita Schalk Programmleitung Kinderbuch



Die Initiative Schöpfung will Sichtbarkeit schaffen für Angebote, Materialien und Initiativen, die sich für Nachhaltigkeit und die Schöpfung einsetzen. Organisationen, Werke, Kirchen und Institutionen sind herzlich dazu eingeladen, Teil des Netzwerks zu werden und mit ihrem Engagement zum Erfolg der Initiative beizutragen.
»Gottes Schöpfung bewundern und sich respektvoll als ein Teil von ihr verstehen. Hoffnung wachhalten gegen alle Bedrohung. Aussprechen, wo Umkehr nötig ist.
Als Christinnen und Christen gemeinsam handeln für Nachhaltigkeit und Klimagerechtigkeit – weltweit und in unserem Land. Dafür steht für mich die ›Initiative Schöpfung‹ und die herzliche Einladung, mit dabei zu sein!«
KRISTINA KÜHNBAUM–SCHMIDT, Evangelische Kirche in Deutschland
ANZEIGEN
Breit angelegte Anzeigen-Kampagne auf Spotify »Initiative Schöpfung« Ideenheft Anders leben




»Man kann nicht mit dem Schöpfer in Frieden leben und mit dessen Schöpfung im Krieg. Zukunft heißt, in unserer Welt wieder neu als Beschenkte zu leben –weil Gott uns diesen Weg weist.«
JÖRG DECHERT, ERF Medien e. V.




PLAKAT A3
»Initiative Schöpfung« Nr. 950.125.002







TISCHAUFSTELLER
»Initiative Schöpfung« Nr. 950.125.004



SAMMELLESEPROBE
»Initiative Schöpfung« – 25er-Set Nr. 950.125.001



AUFKLEBER LOGO
»Initiative Schöpfung« – Bogen mit 48 Stk. Nr. 950.125.003


Unsere Bücher zur INITIATIVE SCHÖPFUNG möchten dabei helfen, dass unsere Gemeinschaft sich aufmacht, um sich für die Schöpfung zu engagieren und für Nachhaltigkeit einzusetzen. Sie bauen eine Brücke zwischen Ideen, bereits entwickelten Projekten sowie interessierten Menschen.
Schöpfung erleben in Kirchen und Gemeinden
























































Das Kampagnen-Buch zur Initiative Schöpfung macht für Christinnen und Christen die Verbindung zwischen Gott, Mensch und Natur frisch erlebbar. Entlang des Kirchenjahrs gibt es geballte Nachhaltigkeit für Gemeinden, kirchliche Gruppen und Initiativen: didaktisch aufbereitet, verortet im Glauben, gespickt mit Aha-Momenten und bunt illustriert. Ganz nach dem Motto: Alles, was wir selbst erlebt haben, was wir selbst gestalten können, das begreifen wir, das bleibt im Gedächtnis. Ein Buch, das eine neue Begeisterung für unseren Schöpfer und seine Geschöpfe weckt.
• 12 Experimente, die die Verbindung zwischen Gott, Mensch und Natur erlebbar machen
• Für die kirchliche Praxis: geballte Nachhaltigkeit, didaktisch aufbereitet
• Für Christinnen und Christen, die eine nachhaltige Gesellschaft mitgestalten möchten


(Jg. 1976) lebt mit ihrer Familie auf einem Bauernhof in Ostthüringen. Die Industriefachwirtin arbeitet im Bereich Unternehmenskommunikation und leitet in ihrer Kirchgemeinde das »Burkersdorfer Krippenspielensemble«. Mit Leidenschaft setzt sie sich für das Thema Bewahrung der Schöpfung ein und engagiert sich in vielen nachhaltigen Projekten.
»Gottes Schöpfung, die uns im Frühling die Auferstehung, im Sommer das Genießen, im Herbst die Dankbarkeit und im Winter die Ruhe predigt, gilt es zu bewahren. Dieses Buch zeigt mit 12 wunderbaren Ideen auf, wie wir als Gemeinden unser ›grünes‹ Erbe erfassen und bewahren können.«
STEFAN KOTHNER, Kirchenmusiker








Mit Themen quer durchs Kirchenjahr:
– Zum Beginn des Kirchenjahres
– Advent
– Weihnachten
– Passionszeit und Ostern
– Pfingsten
– Trinitatiszeit
– Zum Ende des Kirchenjahres
– Totensonntag


Dörte Heyn, EKD (Hrsg.) Bäume pflanzen, die in den Himmel wachsen Mit 12 nachhaltigen Experimenten durch das Kirchenjahr Nr. 227.001.014, € 20,–€[A] 20,60/CHF 27,–* Klappenbroschur, 13,5 × 21,5 cm, 176 S. 4-farbige Innengestaltung
ISBN 978-3-417-01014-5
Erscheint: September 2024







Betsy Painter gibt uns Einblicke in die Welt, wie wir sie vielleicht noch nie gesehen haben: Sie erzählt von Bergen und Mineralien, vom Himmel und von Luft, von Feuchtbiotopen und Korallenri en. Dabei bringt sie nicht nur verblü ende Fakten über die unterschiedlichen Bereiche des Ökosystems, deren Funktio-
Eine gute Mischung aus Wissen, geistlichen Perspektiven und
Praktischem
Durch 4-farbige Illustrationen wird der Text lebendig

• Praktische Schritte für mehr Schöpfungsbewusstsein im Alltag nen und Herausforderungen und auch praktische Umsetzungsideen mit ein, sondern auch eine biblische Perspektive: Die biologische Vielfalt und die unzähligen Arten des Lebens auf der Erde weisen auf die unendliche Kreativität des Schöpfers hin, der alles Lebendige gescha en hat.








und Ökologie in Yale studiert. Sie
ist Naturschutzbiologin, die sich leidenschaftlich für den Umweltschutz einsetzt. Sie hat Theologie und Ökologie in Yale studiert. Sie liebt es, Gott in der Natur zu entdecken und in Bibelgeschichten zu erforschen, was die menschliche Verantwortung gegenüber der Natur ist.
Die Autorin zeigt, was wir über die Umweltkrise wissen müssen und wie der Glaube mit unserem Umgang mit der Schöpfung zusammenhängt. Sie gibt viele praktische Tipps, wie wir selbst aktiv werden können. Dieses Buch verbindet Herz, Kopf und Hand und macht Lust auf hoffnungsvolle Veränderung.«
NAOMI BOSCH, Autorin, Agrarwissenschaftlerin und freie Journalistin (Plentiful Lands)













Betsy Painter, Renate Hübsch (Übersetz.) Seine wundervolle Welt Von majestätischen Gipfeln, wertvollem Süßwasser und unermesslichen Ozeanen –und wie wir sie erhalten
Nr. 396.236, € 23,–€[A] 23,70/CHF 31,10* Gebunden, 13,5 × 21,5 cm, 240 S. 4-farbige Innengestaltung
ISBN 978-3-7751-6236-4
Erscheint: August 2024








Wir würden uns gern für eine lebenswerte Erde einsetzen. Und das kann ganz einfach beginnen. Manchmal sind es die kleinen Schritte, die uns weit nach vorne bringen. Denn wenn viele von uns Veränderungen scha en und dranbleiben, können wir den Wandel sehen, der uns staunen lässt. Anja Schäfer hat 99 Ideen für ein nachhaltigeres Leben zusammengestellt, die sich gut im Alltag ausprobieren lassen. Ein liebevoll gestaltetes Buch für alle, die etwas ändern möchten, ohne sich gleich davon überfordert zu fühlen.

• Praktische Tipps und Ideen für einen nachhaltigeren Alltag
• Liebevoll vierfarbig gestaltet und mit besonderem Einband
• Für alle, die mit kleinen Schritten etwas verändern möchten


studierte Theologie und ist Redakteurin der Zeitschrift »andersLEBEN«. Darüber hinaus schreibt, lektoriert und übersetzt sie freiberuflich Bücher und andere Texte. Sie lebt mit Mann und Kindern in Hamburg.










Anja Schäfer Nachhaltiger leben 99 kleine Ideen, mit denen wir viel bewirken Nr. 629.918, € 12,95 €[A] 13,40/CHF 17,50* Gebunden, 11 × 16,5 cm, 96 S. 4-farbige Innengestaltung
ISBN 978-3-7893-9918-3
Erscheint: September 2024











Ist es nicht erstaunlich, wie Gott sich die Pflanzen, Tiere, Menschen, ja das ganze Universum ausgedacht hat? Alles hat seinen Platz, selbst kleinste Tiere erfüllen eine Funktion, die für das Leben auf der Erde wichtig ist. Von der Erscha ung des Lichts bis zum Menschen lädt dieses außergewöhnliche Bilderbuch dazu ein, die fantasievollen und weisen Werke Gottes zu entdecken. Naturalistische Illustrationen regen zum Staunen über die Schöpfung an, während kindgerecht erklärte naturwissenschaftliche Phänomene den Wissensdurst der Kinder stillen. Hier liegt der Fokus dieses Buchs, das die biblische Schöpfungsgeschichte nutzt, um Faszination für Gottes Wunderwerke zu scha en.

• Klimaneutraler Druck auf Recyclingpapier mit Farben auf Pflanzenölbasis
• Entdeckungsreise durch Gottes Schöpfung, opulent illustriert
• Hochwertiges Geschenk mit aktuellem Thema































ist Autor/Illustrator von zwölf Büchern. Er ist der Illustrator des Bestsellers »The Ology« und seine Naturillustrationen wurden in »The World Book Student Encyclopedia« aufgenommen. Andy ist bekannt für seine realistischen, aber oft auch humorvollen Darstellungen von Wildtieren, Menschen und anderen erstaunlichen Dingen, die Gott gescha en hat.














»Das hat Gott richtig gut gemacht« Nr. 950.130.001




Andy McGuire (Illustr.), Anke Becker (Übersetz.) Das hat Gott richtig gut gemacht! Entdecke seine erstaunliche Schöpfung
Nr. 228.996, € 14,95
€[A] 15,40/CHF 20,20*
Gebunden, 22,8 × 30,4 cm, 48 S. ISBN 978-3-417-28996-1
Erscheint: August 2024
MengeAuswahl Positionen
Bäume pflanzen, die in den Himmel wachsen (227.001.014)
Seine wundervolle Welt (396.236)
Nachhaltiger leben (629.918)
Das hat Gott richtig gut gemacht! (228.996)
Komm, entdecke Gottes bunte Welt! (821.033)
One God. One Planet. One Challenge. (821.077)
GartenGlück (817.987)
GartenGlück – Notizheft-Set (558.419.100)
Und dennoch pflanze ich einen Garten (396.191)
Weltgestalter (396.166)
Besser machen! (835.306)
Ihre individuelle Auswahl bringt bei einer Mindest-Abnahme-Menge satte Rabatte!
Ihre Auswahl Mit Ihrer Auswahl erreichen Sie folgende Paketstufe 9 Positionen 6 Positionen
Stückzahl ermitteln
Ihre Menge Erfüllen Sie die Mindest-Abnahme-Menge 25 Stück 12 Stück
Ihr erreichter Rabatt auf die Bestellung 48%46% GroßKlein
Modulare Pakete erhalten Sie nur über Ihren Vertreter oder bei telefonischer Bestellung über unsere Auftragsbearbeitung.
Volles RR für 18 Monate, Auslieferung: sobald die Titel erscheinen
Dieses Paket finden Sie auch in der Gerth-MedienVorschau auf S. 110/111
Wenn Sie das Verhältnis von Positionen und Stück erreichen –mehr geht natürlich immer –, erhalten Sie satte Rabatte!
Im modularen Paket enthalten












Bäume pflanzen, die in den Himmel wachsen Nr. 227.001.014 Seine wundervolle Welt Nr. 396.236 Nachhaltiger leben Nr. 629.918

Komm, entdecke Gottes bunte Welt! Nr. 821.033


One God. One Planet. One Challenge. Nr. 821.077













Das hat Gott richtig gut gemacht! Nr. 228.996




Und dennoch pflanze ich einen Garten Nr. 396.191

GartenGlück Nr. 817.987




















GartenGlück –Notizheft-Set Nr. 558.419.100











Besser machen! Nr. 835.306









Nr. 396.166





GartenGlück –Aufstellbuch Nr. 821.057






Unsere Bäume der Ho nung Nr. 396.162















Von Bienen, Honig und Gottes großer Güte Nr. 629.892












Ulfie – Die Reise zum Mond Nr. 964.322
Wie Gott die Welt gescha en hat Nr. 228.997
Schweineglück & Lebenslust Nr. 817.267 Erstaunliche Tiere Nr. 228.962
Erstaunliche Tiere – Mein Puzzlebuch Nr. 228.998


Bestell-Nr. Buch 220.000.399
Groß*Klein
10× 5×Fokus (227.001.016) 48%46%Rabatt
77,74 €D40,37 €DNetto-Einkaufswert
149,50 €D 74,75 €DGesamt-Brutto-Verkaufswert
Volles RR für 18 Monate, Auslieferung: September 2024
* Bei der Bestellung von zwei kleinen Vorteilsangeboten erhalten Sie 48 % Rabatt.


»Prüft alles und behaltet das Gute!«
Dieser Planer für das ganze Jahr 2025 bringt mehr Fokus in unseren Alltag und unser Glaubensleben. Die Botschaft lautet: Gott ist ein guter Gott. Und er traut uns zu, das Gute zu wählen. Deshalb dürfen wir mutig entscheiden und lernen zu beurteilen, was wirklich gut ist – und es auch ergreifen. Gleichzeitig fordert das Buch uns heraus, eigene Bewertungskriterien anhand von Gottes Wort zu hinterfragen und auszurichten. Letztendlich geht es darum, Jesus tiefer als den lebendigen und guten Weg kennenzulernen. Das Gute zu wählen, heißt, ihm zu folgen! Ein Begleiter für das ganze Jahr, der die Bibel anhand des Jahresverses erlebbar macht und uns hilft, das Gute in unserem Leben zu wählen.
• Ein Reflexionsplaner, der die Frage beleuchtet, was wirklich gut ist
• Für einen Neustart ins Jahr voller Sicherheit, um gute Entscheidungen zu treffen
• Praktische Aufgaben und Fragen rund um die Jahreslosung 2025

(Jg. 1988) arbeitet als Programmleitung und Lektorin in der SCM Verlagsgruppe. Es ist ihre Leidenschaft, für die unsichtbaren geistlichen und zwischenmenschlichen Dinge eine Sprache zu finden, sodass die Beziehung zu Gott greifbar werden kann. Das tut sie u. a. im HerzforderndPodcast gemeinsam mit ihrer Freundin Antschana (www.herzfordernd.de).
Sammelleseprobe
»Geistliches Leben Herbst 2024« – 25er-Set
Nr. 950.126.001
Lesezeichen
»Fokus« – 25er-Set
Nr. 950.133.001







Lieferbar:







Annalena Pabst Fokus
Alles ändert sich, wenn du wählst, was gut ist. Dein Plan für das Jahr 2025. 1. Thessalonicher 5,21 Nr. 227.001.016, € 14,95 €[A] 15,40/CHF 20,20 Gebunden 14,8 × 21 cm, 144 S. 2-farbige Innengestaltung, mit Leseband ISBN 978-3-417-01016-9
Erscheint: September 2024

Was hat das Thema mit Kindern zu tun?
Wo berührt es ihre Lebenswelt?
Für Kinder ist es unheimlich wichtig zu wissen, dass sie geliebt sind. Es ist die Grundlage dafür, dass sie sich gesund entwickeln und ihr Potential entfalten können. Denn zu spüren, dass sie geliebt sind, gibt ihnen die Sicherheit loszugehen, sich selbst auszuprobieren und mutig Neues zu wagen. Und besonders dann, wenn etwas schiefgelaufen ist oder geschimpft wird, ist es wichtig für sie zu wissen, dass sie trotzdem angenommen sind.


Von Bedeutung ist dabei vor allem das Elternhaus. Das können wir meist nicht beeinflussen. Umso wichtiger ist es aber, dass die Kinder in unseren Gruppenstunden einen Raum erleben, in dem sie angenommen sind und diese Liebe erleben können. Auch wenn es mal Ärger gibt, machen wir miteinander weiter. Dabei ist es ein besonderes Vorrecht, den Kindern die Liebe Gottes zusprechen zu dürfen, die über ihrem Leben steht. Denn diese Liebe ist bedingungslos und gilt unabhängig von allem, was geschieht. Kinder im Vorschulalter verstehen Liebe vor allem als eine emotionale Verbundenheit und als ein Gefühl von Zuneigung zu ihren Eltern, Geschwistern und Freunden. Dabei bringen sie Liebe auch mit Teilen, Trösten und freundlichem Verhalten in Verbindung. Ab dem Grundschulalter entwickeln sie ein stärkeres Verständnis für verschiedene Formen der Liebe. Sie verstehen Liebe nicht nur als emotionale Bindung, sondern auch als Verantwortung, Unterstützung und das gegenseitige Füreinander-Sorgen.

Wichtig ist, dass die Liebe, von der die Jahreslosung spricht, nichts mit dem peinlichen Thema „verliebt sein“ zu tun hat. Vielmehr können die Kinder sich dafür entscheiden, in Liebe zu handeln. Gleichzeitig fällt es vielen Kindern schwer, sich selbst zurückzunehmen und den anderen im Blick zu haben. Besonders dann, wenn es um Gewinnen und Verlieren oder einen persönlichen Vorteil geht.
DURCHFÜHRUNG
ZUR JAHRESLOSUNG
Einstieg
Lieblingsbingo


SITUATION JUNGER ERWACHSENER
Jedes Kind erhält eine Bingo-Vorlage mit der Überschrift „Ich liebe“. Darunter befinden sich verschiedene Begriffe wie: Pommes, Pizza, meine Mama, meinen Papa, meine Geschwister, Mathe, Deutsch, Sport, Fußball, Lesen, Reiten, …
Die Kinder laufen durch den Raum und erfragen, auf wen die unterschiedlichen Aussagen zutreffen. Wer als erstes hinter jeder Aussage einen Namen notiert hat, gewinnt. Allerdings darf jeder Name nur einmal verwendet werden – zumindest, wenn die Gruppe dafür groß genug ist.
Tabu/Pantomime

Die Frage „Wie können wir anderen Menschen Liebe zeigen?“ wird in die Mitte eines großen Plakates geschrieben. Auf kleinen weißen Zetteln stehen unterschiedliche Beispiele wie: nett sein, zuhören, Zeit verbringen, helfen, loben, teilen …
Als ich ein „junger Erwachsener” war, hatte ich das Gefühl, alles verstanden zu haben. Ich hatte das Gefühl, die Welt würde mir gehören. Passend zum Klischee habe ich nach dem Motto gelebt: „Ich weiß, wie der Hase läuft!” Ähnlich ging mir das auch mit Gott und seinem Liebesgebot. Meine Welt war noch klein, fühlte sich aber riesengroß an. Ich dachte, dass es ja nicht so schwer sein kann, seinen Nächsten zu lieben und alles in Liebe zu tun. Diese Einstellung von mir lag daran, dass ich „nur” studieren durfte. Heute bin ich 35 Jahre alt, habe eine Arbeit, eine Familie, einen teilweise vollen Alltag. Und ich merke, dass ich eigentlich doch viel weniger weiß, als ich mit Anfang 20 noch gedacht habe. Und dass es eben kein Selbstläufer ist, den Nächsten zu lieben. Weil das im trubeligen Erwachsenenalltag für mich viel häu ger untergeht, als das noch vor ein paar Jahren der Fall war, als „junger Erwachsener“, mitten im Studium. Zumindest fühlt es sich so an. Wie ist das bei den jungen Erwachsenen, die bei dir in die Gruppe gehen? An welchem Punkt stehen sie, was glauben sie, wie weit ist ihr Horizont?
DURCHFÜHRUNG EINER GRUPPENSTUNDE
ZUR JAHRESLOSUNG
1.Einstieg
Zu Beginn dieser Gruppenstunde wird es kreativ. Gib jedem deiner jungen Erwachsenen ein DIN-A4-Blatt und Stifte. Nun lass die Leute einfach mal aufmalen oder aufschreiben, wie für sie

dieses „Alles” aus der Jahreslosung aussieht.
Was kann das konkret im Leben der oder des Einzelnen bedeuten „alles in Liebe zu tun”? Was würde dazugehören? Welche Menschen, Situationen, beru ichen Umstände?
ge
Am Ende könnt ihr eure Bilder miteinander vergleichen und gegenseitig schauen, was euer „Alles” jeweils ist.

2.Begegnung mit der Jahreslosung

Spielerische Übung: Systemische Dreiecke Für diese Übung stellen sich alle Teilnehmenden im Kreis auf und suchen sich jeweils im Geheimen zwei Personen aus dem Kreis aus. Nach einem gemeinsamen Startschuss besteht die Aufgabe darin, dass jede Person ein gleichschenkliges Dreieck mit ihren zwei im Geheimen „Auserwählten“ bilden soll. Sobald dieses Dreieck gebildet wurde, bleibt die Person stehen. Wird das Dreieck danach wieder aufgelöst, weil die beiden anderen Menschen sich bewegen, muss die Person wieder losgehen und ein Dreieck bilden. Erfahrungsgemäß dauert diese Übung immer ein bisschen, bis alle Dreiecke gebildet sind und alle Personen stehen bleiben können.
Diese Übung zeigt sehr schön, dass alles miteinander zusammenhängt. Bewege ich etwas an der einen Seite des Dreiecks, bewegen sich mitunter viele andere Ecken mit. Eine Bewegung verursacht viele andere Bewegungen und schon ist alles in Bewegung.

Doppelseiten Teens/junge
Ein Set von 10 Postkarten mit je einem Motiv für Kinder oder Teenager bzw. junge Erwachsene zur Jahreslosung sowie einer Broschüre mit drei verschiedenen Stundenentwürfen für Gruppen unterschiedlichen Alters (Kinder, Teenager, junge Erwachsene). Die Jahreslosungskarten können beispielsweise in der Kleingruppe verteilt werden. Mit dem Stundenentwurfsheft gelingen Gruppenstunden zum Thema der Jahreslosung 2025. Enthalten sind Erklärungen zum Bibelvers und dessen Kontext, Betrachtungen zur Bedeutung des Verses für die unterschiedlichen Zielgruppen sowie praktische Ideen und Methoden für die Gestaltung einer Gruppenstunde.
• Karten für Kinder oder Teenager bzw. junge Erwachsene, Arbeitsmaterial für die Mitarbeitenden
• 3 Stundenentwürfe für unterschiedliche Zielgruppen in einem Heft
• Damit gelingt die Gruppenstunde zur Jahreslosung bestimmt!





Motiv gestaltet von Joy Katzmarzik




Motiv mit Unterstützung von KI durch Dieter Betz gestaltet
Ingo Müller, Annkatrin Edler, Ruben Ullrich Jahreslosung 2025 –Stundenentwurf und Postkarten (10 Ex.) für (Jungschar)Kinder Prüft alles und behaltet das Gute! (1. Thess. 5,21)
Nr. 182.647, € 11,95
€[A] 12,30/CHF 16,10*
Stundenentwurf: Broschiert
10,5 × 14,8 cm, ca. 40 S. 10 Postkarten
ISBN 978-3-87092-647-2
Erscheint: September 2024
Ingo Müller, Annkatrin Edler, Ruben Ullrich
Jahreslosung 2025 –Stundenentwurf und Postkarten (10 Ex.) für Teens und junge Erwachsene Prüft alles und behaltet das Gute! (1. Thess. 5,21)
Nr. 182.648, € 11,95
€[A] 12,30/CHF 16,10*
Stundenentwurf: Broschiert
10,5 × 14,8 cm, ca. 40 S. 10 Postkarten
ISBN 978-3-87092-648-9
Erscheint: September 2024




Rückseite
































































PRESSE/PR











VISITENKARTENKALENDER
»Jahreslosung 2025« – 25er-Set Nr. 950.107.025



Beitrag in: Die Gemeinde Geistl. Gemeindeerneuerung AUFATMEN
Interview in: Faszination Bibel

Bestell-Nr. 227.001.025














SAMMELLESEPROBE



»Geistliches Leben Herbst 2024« – 25er-Set Nr. 950.126.001
Display »Jahreslosung 2025«
10 ×Prüft alles und behaltet das Gute (227.001.009)
1 × Display 48%Rabatt 51,74 €DNetto-Einkaufswert inkl. MwSt. 99,50 €DGesamt-Brutto-Verkaufswert
Volles RR für 18 Monate, Auslieferung: September 2024


lohnt sich!

Bewährt und seit vielen Jahren beliebt: Das Jahreslosungsbuch darf auch 2025 nicht fehlen. Auf biblisch fundierte und praktisch motivierende Weise reflektiert Kerstin Wendel mit uns darüber, was es bedeutet, dem Heiligen Geist mehr Raum zu geben, sein Reden und Wirken in unserem Leben zu prüfen und uns nachhaltig davon verändern zu lassen. Es erwarten uns nicht nur geistliche Erkenntnisse und ein tiefer Blick in die Bibel, sondern das Wissen wird auch in unserem persönlichen Alltag anwendbar.

»Kerstin Wendel schenkt uns in diesem Buch zur Jahreslosung eine Fülle von guten Gedanken. Sie gibt Spielregeln weiter, wie das Prüfen verantwortlich geschehen kann. Sie lädt ein, auf das Gute zu sehen. Und eröffnet den Weg in eine große Freiheit des Glaubens.«
MARTIN GUNDLACH, Chefredakteur AUFATMEN und Redaktionsleiter SCM Bundes-Verlag



















www.kerstin-wendel.de




















• Ein gründlicher Blick auf die Jahreslosung 2025
www.speakerinnenplattform.de








• Mix aus biblischem Wissen und praktischen Impulsen
• Wunderbares Geschenk zu Weihnachten oder zum Jahreswechsel
Kerstin Wendel (Jg. 1965) lebt mit ihrem Mann in Wetter/Ruhr. Sie ist Autorin, Speakerin und Seminarleiterin. Ehrenamtlich engagiert sie sich in der ruhrkirche, zuletzt leitend im Bereich Gottesdienst. In ihrer Freizeit ist sie am liebsten draußen in der Natur oder liest.
Instagram: @kerstin.wendel.lavendel
Kerstin Wendel Prüft alles und behaltet das Gute Das Buch zur Jahreslosung 2025 Nr. 227.001.009, € 9,95 €[A] 10,30/CHF 13,40* Gebunden 10,5 × 16,5 cm, 144 S. ISBN 978-3-417-01009-1
Erscheint: September 2024
»Ich liebe die Vision für unser Leben, die John Mark Comer hier rüberbringt! So hilfreich für alle von uns, die wir mit Jesus unterwegs sind.«
NICKY GUMBEL, alpha.org
»Das Beste an diesem Buch: Während man liest, will man sich einfach nur noch an die Fersen von Jesus heften. Jesus so nah zu sein, bringt uns zum eigentlichen Sinn unseres Daseins zurück.«
JENNIE ALLEN, ifgathering.com
für Ihren Verkaufserfolg:


PLAKAT A3
»Comer: Leben vom Meister lernen« Nr. 950.122.002


LESEPROBE
»Comer: Leben vom Meister lernen« – 25er-Set Nr. 950.122.001
PRESSE/PR
Beitrag in: AUFATMEN LebensLauf andersLeben
ANZEIGEN
AUFATMEN Christsein heute Dran Hauskreismagazin
Family MOVO Willow Magazin
TRAILER zum Bucherscheinen
















































































































Vorteilsangebot »Leben vom Meister lernen«
Bestell-Nr. Buch 220.000.400
Groß*Klein
10×5×Leben vom Meister lernen (227.001.015)
48%46%Rabatt
119,60 €D62,10 €DNetto-Einkaufswert
230,– €D115,– €DGesamt-Brutto-Verkaufswert
Volles RR für 18 Monate, Auslieferung: Juni 2024
* Bei der Bestellung von zwei kleinen Vorteilsangeboten erhalten Sie 48 % Rabatt.


Bei Jesus sein. Jesus ähnlich werden. Handeln, wie er es tat.
Jüngerschaft – was ist das, wie geht das? Wie folgen wir dem Rabbi Jesus heute nach – wo wir ihn nicht mehr greifbar um uns haben? Gewohnt provokant stellt John Mark Comer in seinem neuen Buch Aussagen in den Raum, an denen man nicht einfach vorbeigehen kann. Aussagen, die eine Reaktion, ein Umdenken und Neudenken einfordern. So zum Beispiel: Jesus war als Rabbi, als Lehrer, unterwegs. Er hat nicht Christen hervorgebracht, keine Kirche gegründet. Sein erstes Ziel war nicht mal sein Sterben. Nein! Er hat einen völlig neuen Lebensstil vorgelebt und Menschen gerufen, Leben von ihm zu lernen. Dabei geht es nicht zuerst ums Fertigwerden, sondern darum, den Weg einzuüben.
• Das Jüngerschaftsbuch von Erfolgsautor John Mark Comer
• Ein biblisches Verständnis erlangen, was ein Jünger ist, was er tut und was nicht
• Augenöffnend, herausfordernd, befähigend

 John Mark Comer
John Mark Comer
(Jg. 1980) lehrt und lebt im Großraum Los Angeles, USA. Er ist Gründer der »Bridgetown Church« in Portland, Oregon und wirkt seit 2021 in der »Vintage Church LA«. Als Autor und mit seinen Podcasts ist er international erfolgreich. Er hat die Initiative »Practicing the Way« ins Leben gerufen, um Ortsgemeinden mit Ressourcen für Jüngerschaft und zur geistlichen Entwicklung zu unterstützen.
www.johnmarkcomer.com www.practicingtheway.org
Die neun Kernpraktiken der geistlichen Lebensregel nach John Mark Comer: Sabbat, Abgeschiedenheit, Gebet, Fasten, Bibel, Gemeinschaft, Großzügigkeit, Dienst, Zeuge sein








Lieferbar:












John Mark Comer, Renate Hübsch (Übersetz.) Leben vom Meister lernen Practicing the Way
Nr. 227.001.015, € 23,–€[A] 23,70/CHF 31,10 Gebunden 13,5 × 21,5 cm, 288 S. mit Coververedelung
ISBN 978-3-417-01015-2
Erscheint: Juni 2024




• Ein neues Andachtsbuch in der erfolgreichen Reihe
Das Männer-Andachtsbuch ist seit Jahren ein Erfolgskonzept. MOVOChefredakteur Rüdiger Jope sammelt Erlebtes und Erprobtes von Autoren und Papas, Pastoren und Kumpels. Das Leben als Männer und Christen gleicht einem Aufstieg. Schwieriges gehört dazu. Doch wir sind Gehaltene. Der Weg durch herausfordernde Hängepartien muss nicht einsam sein oder gar haltlos! Trotz blauer Flecken, schmerzhafter Beulen und unkonzentrierter Abrutscher – bei Gott ist unser Leben stabil gesichert. Die 53 Andachten laden Männer ein, sich für die persönliche Lebensklettertour bei Gott einzuklinken.
• 53 praktische Impulse in lebensnaher Sprache für Männer
• Gehaltvolle Texte zum Auftanken rund um das Thema »Sicherheit bei Gott«
Rüdiger Jope (Hrsg.)
Karabiner
Das Männer-Andachtsbuch
Nr. 227.001.020, € 14,95
€[A] 15,40/CHF 20,20* Gebunden
12,5 × 18,7 cm, 192 S. ISBN 978-3-417-01020-6
Erscheint: September 2024
Vorteilsangebot »Karabiner«
Bestell-Nr. Buch 220.000.405
Groß*Klein
10× 5×Karabiner (227.001.020) 48%46%Rabatt
77,74 €D40,37 €DNetto-Einkaufswert
149,50 €D 74,75 €DGesamt-Brutto-Verkaufswert
Volles RR für 18 Monate, Auslieferung: September 2024
* Bei der Bestellung von zwei kleinen Vorteilsangeboten erhalten Sie 48 % Rabatt.
Geistliches Leben
Daniel Grothe erkennt eine Tendenz unter Christen, unter dem Deckmantel der Sendung zu verpassen, Zugehörigkeit und echte Heimat zu finden. Sein Buch ist ein Augenö ner für alle, die sich schon längst fragen, warum sie eigentlich nie den Mut hatten, an einem Ort mit einer bestimmten Anzahl von Menschen anzukommen und tiefe Wurzeln zu schlagen. Es ermutigt dazu, in einer Zeit der Schnelllebigkeit den eigenen Platz im Hier und Jetzt zu finden und die Kraft von Stabilität –geistlich und physisch – neu wertzuschätzen. Ein Buch, das uns den Mehrwert von echter Hingabe, Ortsverbundenheit und dem tiefen Schatz des Bleibens neu vor Augen führt.
Sammelleseprobe
»Geistliches Leben Herbst 2024«
– 25er-Set
Nr. 950.126.001
TRAILER
zum Bucherscheinen





• Die Maßstäbe Gottes für ein »effektives« Leben in Nachfolge ergreifen
• Ein geistlicher Kontrapunkt zur »Höher, schneller, weiter«-Kultur unserer Zeit
• Spricht Menschen an, die sich ruhelos fühlen und nach Zugehörigkeit und Sicherheit sehnen

Daniel Grothe ist seit 2005 Pastor in der »New Life Church« in Colorado Springs, USA. Vor seinem Theologiestudium war Daniel als Schlagzeuger mit christlichen Musikern wie Gungor, The Brilliance oder Darrell Evans unterwegs. Mit seiner Frau Lisa und den drei Kindern lebt Daniel auf einer Hobby-Ranch in der Nähe von Colorado Springs. www.danielgrothe.com
Daniel Grothe, Renate Hübsch (Übersetz.) Die Kraft des langsamen Glaubens Platz nehmen und bleiben, wo Gott mich meint Nr. 227.001.018, € 20,–€[A] 20,60/CHF 27,–* Klappenbroschur 13,5 × 21,5 cm, 240 S. ISBN 978-3-417-01018-3
Erscheint: September 2024











... fängt Glaube erst an Sicherheit – wir haben ein großes Bedürfnis danach. Gerade hier in Europa boomt das Abschließen von Versicherungen jeder Art. Für die Nachfolge von Jesus gibt es allerdings keine Versicherung. Ganz im Gegenteil: Erst, wenn wir bereit sind, alles loszulassen, fängt das Leben im Glauben an! Friedhelm Holthuis motiviert in seinem Buch dazu, als Nachfolger von Jesus wieder risikofreudig zu werden. Er beleuchtet einige der zentralen Glaubenshelden aus der Bibel, teilt persönliche Glaubensschritt-Momente und er ruft uns in Erinnerung, wie vertrauenswürdig unser Gott ist: Der, an den wir glauben, ist tatsächlich allmächtig!
• Neue Motivation, im Glauben bewusst Risiko einzukalkulieren
• Ein Glaubensbooster für alle, die sich ein neues Level in ihrer Nachfolge wünschen
• Locker geschrieben und leicht zu lesen – erfrischt und aktiviert



 Friedhelm Holthuis
Friedhelm Holthuis



(Jg. 1971) ist Seniorpastor der »Credo Kirche«, einer Gemeinde mit fünf Standorten. Relevante, sich multiplizierende Gemeinden liegen ihm am Herzen – er träumt davon, in jeder Stadt und in jedem Dorf eine Kirche zu sehen, in der man Gott begegnen kann. Er ist als Sprecher im In- und Ausland tätig und seit September 2022 Präses im »Bund Freikirchlicher Pfingstgemeinden« (BFP). Mit seiner Familie lebt er in der Nähe von Wuppertal.
www.credo-kirche.de
Sammelleseprobe
»Geistliches Leben Herbst 2024« – 25er-Set
Nr. 950.126.001


»Dieses Buch ist eine kraftvolle Ermutigung für jeden, der danach strebt, die Wellen des Lebens zu durchbrechen. Friedhelm Holthuis macht sichtbar, wie das Vertrauen auf Gott uns befähigt, über unsere Grenzen hinauszuwachsen und außergewöhnliche Dinge zu vollbringen. Es ist nicht nur ein Buch – es ist eine Einladung und ein Wegweiser, um das Unerwartete zu umarmen und das Abenteuer des Glaubens zu leben. «
ANDREAS SOMMER, Hoop Kirche Bremen



Friedhelm Holthuis Glaube = Risiko Erlebe, dass du Gott vertrauen kannst Nr. 227.001.019, € 20,–€[A] 20,60/CHF 27,–Klappenbroschur 13,5 × 21,5 cm, 224 S. ISBN 978-3-417-01019-0
Erscheint: September 2024





Was ist das Bedeutendste im Leben? Für den Apologetiker Simon Edwards sind das Sinn, Wert, Güte, Wahrheit, Liebe, Ho nung und Leid. In seinem Buch führt er seine Leser von diesen Themen aus und anhand seiner persönlichen Geschichte in die tiefe Frage nach dem Sinn des Lebens. Wie lassen sich in unserer Zeit heute die großen Fragen des Lebens beantworten? Er stellt den Werten des Zeitgeists den christlichen Glauben gegenüber und führt nahbar, sprachlich elegant und überzeugend aus, warum Glaube eine vernünftige Sache ist, die die Ratio nicht ausschließt, sondern die menschliche Suche nach Sinn und die Logik zu befriedigen vermag.
Sammelleseprobe
»Geistliches Leben Herbst 2024« – 25er-Set
Nr. 950.126.001
• Ein zeitgemäßer Zugang zu Apologetik, Glaube und zum Zweifeln
• Tiefer verstehen, warum sich Vernunft und Glaube optimal ergänzen
• Ein denkerisch überzeugendes Statement für Fundamente des christlichen Glaubens
Simon Edwards, Renate Hübsch (Übersetz.)
Ich denke, also glaube ich?
Was dem Leben Bedeutung gibt
Nr. 227.001.024, € 20,–€[A] 20,60/CHF 27,–* Gebunden
13,5 × 21,5 cm, 240 S. ISBN 978-3-417-01024-4
Erscheint: September 2024

Simon Edwards ist international als Sprecher im kirchlichen, akademischen und im Business-Kontext unter wegs. Sein Fokus richtet sich dabei auf die tiefen Lebensfragen unserer Zeit und die wirklich bedeutenden Antworten im christlichen Glauben. Er hat an der »Oxford University« sowie am »Oxford Centre for Christian Apologetics (OCCA)« Theologie studiert, wo er heute unterrichtet.
»Identität
»Nun lebe nicht mehr ich, sondern Christus lebt in mir.« Diese Realität aus dem Galaterbrief wurde Lebensgrundlage für Ian Thomas. Es ist unmöglich, aus eigener Anstrengung Gottes Geboten zu entsprechen. Doch Christus lebt in uns und mit ihm auch die Erfüllung aller Anforderungen des Gesetzes. Der Autor zeigt in diesem weltbekannten Buch, wie Christen die Auferstehungskraft existenziell erfahren können. Aus einem eintönigen Glauben wird ein dynamisches und glaubwürdiges Leben, das im Alltag Kraft entfaltet, die aus Gott kommt, und jeden Moment aus seiner Gegenwart nimmt.
Sammelleseprobe
»Geistliches Leben Herbst 2024«
– 25er-Set Nr. 950.126.001
»Das ist Evangelium auf den Punkt gebracht!
Eine enorme Hilfe, um zu verstehen, wie ich all die guten Ideen von Jesus in den Alltag bekomme, und woher die Kraft kommt, das Evangelium zu leben. «
ELMAR OTTO,
Kurzbibelschule Schloss Klaus, Fackelträger Österreich





• Mit einem neuen Vorwort von Peter Reid, Fackelträgerzentrum Bodenseehof
• Für alle, die die geistlichen Wurzeln neu wertschätzen möchten
• Der Klassiker zum Thema »Identität in Christus« neu aufgelegt
Lieferbar:













W. Ian Thomas Christus in euch Dynamik des Lebens
Nr. 227.001.021, € 17,–
€[A] 17,50/CHF 23,–* Gebunden
13,5 × 21,5 cm, 160 S. ISBN 978-3-417-01021-3
Erscheint: Juni 2024




Was wäre, wenn uns Maria, Petrus, Johannes, die Frau am Jakobsbrunnen und andere Zeitzeugen Jesu persönlich von ihren Erlebnissen berichten würden? Und wir dabei entdeckten, dass sie Menschen waren wie du und ich? Fabian Vogt lässt vierzig Frauen und Männer der Bibel mit leuchtenden Augen erzählen, wie sie Jesus begegnet sind und wie diese Erfahrung sie verändert hat – ein Lesevergnügen zum Selbst-Genießen oder als bewegende Andachten, die uns anregen, über unsere eigenen Glaubenserfahrungen nachzudenken. Mit inspirierenden Fragen zum Weiterdenken, auch für Gruppen.
• Petrus, Paulus & Co. berichten auf bewegende Weise von ihrer Begegnung mit Jesus
• Ein Buch voller Inspiration, über unsere eigene Geschichte mit Jesus zu reflektieren
• Mit Fragen zum Selbstnachdenken oder für die Gruppendiskussion


(Jg. 1967) ist Schriftsteller, Theologe und Künstler. Er arbeitet bei »midi«, der Zukunftswerkstatt für Kirche und Diakonie in Berlin –wenn er nicht gerade nach neuen Geschichten schürft.
Sammelleseprobe
»Geistliches Leben Herbst 2024« – 25er-Set
Nr. 950.126.001




» Spannende, weise, liebenswerte Persönlichkeiten stellt Fabian Vogt uns vor. Im Prinzip kennen wir sie aus dem Neuen Testament. Hier aber kommen sie uns als Menschen zwischen Angst und Hoffnung, Glauben und Zweifeln nahe. Besonders wertvoll: Beim Lesen entdecken wir Szenen, Randfiguren und Inhalte aus den Evangelien neu oder tiefer. Ein Lesevergnügen mit Tiefgang!«
CHRISTOPH ZEHENDNER, Theologe, Liedermacher und Autor
Lieferbar:




Nr.
»Fabian Vogt wagt den Perspektivwechsel und erzählt, wie es gewesen sein könnte, als Menschen aus der Bibel Gott erlebten. Sind die Geschichten historisch korrekt? Vielleicht. Sind sie wahr? Unbedingt! Die Geschichten laden ein weiterzudenken, weiterzuhoffen und weiterzuglauben. «
SUSANNE OSPELKAUS, Autorin



Fabian Vogt
Mit leuchtenden Augen
40 biblische Begegnungen mit Jesus, die bis heute Kraft haben
Nr. 227.001.017, € 17,–€[A] 17,50/CHF 23,–* Gebunden
12,5 × 18,7 cm, 208 S. ISBN 978-3-417-01017-6
Erscheint: Juni 2024

»Das Buch ist wie ein Puzzle: Jede der elf Geschichten erzählt vom Leben der Christinnen und Christen im Osten Deutschlands.

Gebürtige ›Wessies‹ werden viel Neues lernen –und Leser aus dem Osten der Republik werden sich in vielem wiederfinden. So trägt dieses Buch dazu bei, einander besser zu verstehen.«






MARTIN GUNDLACH, Chefredakteur AUFATMEN






LESEPROBE
»Ramsden: Herzen ohne Mauer« – 25er-Set Nr. 950.123.001





ANZEIGEN
Glaube + Heimat
Der Sonntag Christsein heute Family
Lebenslauf
Börsenblatt Idea
TRAILER zum Bucherscheinen
PRESSE/PR

Lesereise/ Releaseveranstaltung
Beitrag in: AUFATMEN LebensLauf lebenslust










Es geht nicht um das, was uns trennt, sondern um das, was wir gemeinsam haben.




»Das ist nicht einfach nur etwas für den Kopf. Das geht ins Herz. Und genau da – im Herzen –brauchen wir wieder mehr Nähe zueinander in unserem Land. Das setzt aber voraus, dass wir unser Herz von der Geschichte des anderen bewegen lassen. Und genau das schaffen die Biografien in diesem Buch.«


FRANK DÖHLER, Pastor FeG »Goldenes Lamm« Dresden















































































Ich dachte, jetzt wird alles gut Endlich frei und vereint: 1989 erfüllte sich für die Christen der DDR ein lang ersehnter Traum. Auf dem langen Weg in die Freiheit haben sie für ihren Glauben viele Opfer bringen müssen. Trotz aller Hindernisse sind sie ihrem Gott treu geblieben. Doch mit der neu gewonnenen Freiheit taten sich nicht nur neue Horizonte, sondern auch neue Fragen und Probleme auf. Mit den DDR-Erfahrungen aus ihrer eigenen Kindheit wirft Autorin Viola Ramsden einen genaueren Blick auf das Leben ostdeutscher Christen. Sie hat mit ihnen ganz persönlich gesprochen: über die kirchenfeindliche DDR-Zeit, die mutigen Tage der friedlichen Revolution, die Umbrüche der Wende bis hin zu den Herausforderungen im Heute.

• Elf wahre Lebens- und Glaubensgeschichten aus dem geteilten Deutschland


• Gibt ganz neue, exklusive Einblicke in das Alltagsgeschehen der DDR
• Entfacht den Wunsch nach wahrer Einheit







(Jg. 1976) wurde in der DDR geboren und studierte Germanistik und Anglistik in Marburg. Sie lebte und arbeitete 13 Jahre in London, bis es sie mit Mann und Kind wieder nach Sachsen zog. Sie liebt das Schreiben, ihre Familie und den Osten.
»Christsein hat in der DDR viel gekostet, das hat man nur gemacht, wenn man es wirklich wollte.«
www.myostblog.wordpress.com





Pastor i. R. JOHANNES HOLMER

»Herzen
Bestell-Nr. Buch 390.000.408
Groß*Klein
10×5×Herzen ohne Mauer (396.135) 48%46%Rabatt
119,60 €D62,10 €DNetto-Einkaufswert 230,– €D115,– €DGesamt-Brutto-Verkaufswert
Volles RR für 18 Monate, Auslieferung: September 2024
* Bei der Bestellung von zwei kleinen Vorteilsangeboten erhalten Sie 48 % Rabatt.



»Ist es nicht so? Oft hören wir nur das, was wir verstehen oder hören wollen. Dieses Buch ist die Einladung, neu hinzuhören, um besser zu verstehen. Wer die Prägungen und Lebensgeschichten eines Menschen kennt und versteht, kann Brücken sehen, wo sonst oft Gräben das Miteinander unmöglich machten. «
Viola Ramsden
Herzen ohne Mauer Wie Christen die DDR, die Friedliche Revolution und die Zeit danach erlebten
Nr. 396.135, € 23,–€[A] 23,70/CHF 31,10* Gebunden

13,5 × 21,5 cm, 288 S. mit Leseband
ISBN 978-3-7751-6135-0
Erscheint: September 2024




Zwei Herzen, die schlagen – wörtlich und im übertragenen Sinn, das ist der Kernaspekt beim Thema Abtreibung: der Konflikt zwischen Mutter und Kind, zwischen Lebensrecht und Selbstbestimmungsrecht, manchmal auch zwischen Herz und Verstand. Wie können wir gut mit dieser Spannung umgehen? Kann man »Pro Life« und »Pro Woman« sein? Oder bedeutet Lebensschutz, sich nur für das Leben des ungeborenen Kindes zu interessieren? Antworten auf diese und weitere Fragen gibt Sabina Scherer anhand gängiger Argumente und persönlicher Erfahrungen. Ihr empathischer Schreibstil ermöglicht es, sich eine fundierte Meinung zu bilden, ohne negative Stereotype oder Klischees zu produzieren.

• Ausgewogen, fundiert, empathisch
• Ermöglicht ein tieferes Verständnis zum Thema Lebensschutz

• Autorin ist eine der bekanntesten Pro-Life-Aktivistinnen



(Jg. 1990) ist Psychologin und startete in ihrer Elternzeit einen Podcast über das Thema Abtreibung. Dadurch wurde sie als junge Stimme der Lebensschutzbewegung bekannt und vertritt diese nun unter anderem auf Social Media. Sie lebt mit ihrer Familie in Bayern.
Presse/PR
Zu Gast bei: ZDF 13 Fragen





PODCAST der Autorin


»Ein Zellhaufen spricht über Abtreibung. Jetzt schreibt er auch noch. Und wie: Klar, kompetent, mit bestechender Logik und gleichwohl empathisch. Konstruktiv statt destruktiv, wertschätzend statt verurteilend. Eine der besten Verteidigungen des Lebensrechts ungeborener Kinder, die es je gab. «
STEFAN REHDER, Journalist, Buchautor und Bioethik-Experte
»Dieses Buch ist ein bedeutender und umfassender Beitrag zur Pro-Life-Bewegung, der hoffentlich einige der Vorurteile gegen diese abbaut und mehr Menschen verstehen hilft, warum das Leben ungeborener Menschen genauso wertvoll ist und es sich lohnt, dafür zu kämpfen. Wir empfehlen die Lektüre dieses Buches jedem, der Antworten und Wissen zu diesem Tabuthema sucht. «
ALICIA UND ANDREAS DÜREN, sundaysforlife




Sabina M. M. Scherer Mehr als ein Zellhaufen Wie wir konstruktiv über Abtreibung sprechen können Nr. 396.212, € 20,–€[A] 20,60/CHF 27,–* Gebunden
13,5 × 21,5 cm, 224 S. ISBN 978-3-7751-6212-8
Erscheint: Juni 2024




Überarbeitete Neuausgabe


Auch in Deutschland werden immer mehr Fälle religiösen Missbrauchs bekannt. Daher sind gute Informationen unerlässlich, um mit heiklen Situationen und betro enen Menschen sensibel umzugehen. Dieses Buch geht der Frage nach der Definition des Missbrauchs ebenso nach wie den verschiedenen Ursachen missbräuchlicher Situationen. Außerdem zeigt Inge Tempelmann in feinfühliger Weise die Folgen von frommer Gewalt und mögliche Wege der Heilung auf. Ein Standardwerk für alle, die mit religiösem Missbrauch in all seinen Facetten in Berührung kommen. Grundlegend überarbeitete Neuauflage des Klassikers.
»Die langjährige Expertin für geistlichen Missbrauch Inge Tempelmann hat eine reife Zusammenfassung ihrer Forschungen geschrieben: aufrüttelnd, hilfreich für Betroffene und orientierend für alle, die wollen, dass Kirche ein sicherer Ort ist. Der Umgang mit Macht in der Kirche ist das entscheidende Thema für ihre Glaubwürdigkeit. «
DR. THORSTEN DIETZ, Autor und Podcaster
• Hilfreich zur Aufklärung über ein aktuelles Thema
• Bereits in 6 Auflagen erschienen
• Für Betroffene, Berater und Menschen in Leitungspositionen
Inge Tempelmann
Religiöser Missbrauch
Auswege aus frommer Gewalt –Ein Handbuch für Betro ene und Berater
Nr. 396.205, € 28,–
€[A] 28,80/CHF 37,80* Gebunden
13,5 × 21,5 cm, 432 S. mit Leseband
ISBN 978-3-7751-6205-0
Erscheint: August 2024

Inge Tempelmann (Jg. 1962), M. A. Religion und Psychotherapie, lebt in Lüdenscheid und ist als Supervisorin, Coach, psychologische Beraterin und Referentin freiberuflich tätig. Die Begleitung von Menschen, die mit missbräuchlichen Dynamiken im frommen Gewand in Berührung kamen, sowie Projekte zu dieser Thematik sind seit Jahren ein Schwerpunkt ihrer Arbeit.
In Hannahs Familie sieht nach außen hin alles glänzend aus – doch hinter geschlossenen Türen weht ein anderer Wind. Toxische Beziehungen sind geprägt von einer nur schwer durchschaubaren Atmosphäre. Im Nebel der Manipulation bleiben oft nur Verwirrung und Verzweiflung zurück. Saraj Stutz erklärt auf verständliche und nahbare Weise die Abläufe, Taktiken und Rollenverteilungen in destruktiven Beziehungen und gibt dem Leser damit eine »Nebelsichtbrille« an die Hand. Nicht zuletzt zeigt sie den Weg aus den Mustern des narzisstischen Missbrauchs auf – hinaus aus diesem »Ägypten« in ein neues Land, in dem das Leben wieder blühen darf.
Mit einem Fachlektorat von WOLFRAM SOLDAN, IGNIS-Akademie
Presse/PR
Interview in: Lydia
»Mein Fazit: Ein ehrliches, in die Tiefe gehendes, für Betroffene heilsames und für professionelle Helfer hilfreiches Buch.«
WOLFRAM SOLDAN, Arzt, Psychotherapeut und Supervisor (ACC)

• Ein lebensnaher Zugang zum Thema toxische Beziehungen
• Praktisch, einfühlsam, verständlich – ein echtes Lebenshilfe-Buch!
• Mit vielen Illustrationen und Übungen für Betroffene und Berater

Saraj Stutz (Jg. 1983) ist eine christlich-psychologische Beraterin, erfahren in der Behandlung von posttraumatischen Belastungsstörungen. Einen besonderen Schwerpunkt legt sie auf eine körperzentrierte, gestalterische Therapieform. Sie lebt und praktiziert im Raum Thun. www.sarajstutz.ch
Saraj Stutz Damit sich der Nebel lichtet Toxische Beziehungsmuster hinter frommen Fassaden erkennen und heil werden
Nr. 396.241, € 25,–€[A] 25,70/CHF 33,80* Klappenbroschur 13,5 × 21,5 cm, 336 S. ISBN 978-3-7751-6241-8
Erscheint: August 2024





• Voller Impulse, die Beziehungen auf ein festes Fundament stellen
Wenn wir heiraten, haben wir ein gemeinsames Leben vor uns, dem wir voller Ho nung entgegensehen. Was wir aneinander haben, ist unendlich wertvoll! Wie wichtig es gleichzeitig ist, auch in die Vergangenheit zurückzublicken und Prägungen aus der Herkunftsfamilie aufzuarbeiten, zeigt dieses Buch. O en und ehrlich berichtet die Autorin von ihren Erfahrungen und führt Paare auf persönlicher Ebene einen Weg, der die Beziehung stärkt, ihr Vision vermittelt und sie grundlegend gesund aufstellt. Ein ermutigendes und praktisches Buch für einen lebendigen, liebevollen und lebenslangen Ehealltag.
Presse/PR Beitrag in: Family ERF Teensmag Mindo Magazin
»Ein inspirierender Ratgeber voller Leidenschaft für starke Ehen! Die persönliche Geschichte der Autorin verleiht diesem Buch Authentizität und Tiefe. Die gelungene Mischung aus Theorie und praktischen Anwendungen macht es zu einem wertvollen Begleiter für alle, die ihre Partnerschaft vertiefen möchten.«
MARC BARETH, Leiter FAMILYLIFE Schweiz
• Hat das Potenzial zum Klassiker für junge Paare –praktisch und lebensnah: auch ideal als Hochzeitsgeschenk
• Mit einem neuen Fokus auf Biografiearbeit und Herkunftsfamilie
Ira Schneider
Jeden Tag ein neues Ja Unsere Ehe als Gestaltungsraum entdecken und eine Segenslinie ziehen
Nr. 396.240, € 23,–
€[A] 23,70/CHF 31,10* Gebunden, Goldprägung, 13,5 × 21,5 cm, 240 S. 2-farbige Innengestaltung
ISBN 978–3-7751-6240-1
Erscheint: Juni 2024

Ira Schneider arbeitet als Paartherapeutin und Autorin. Zudem ist sie als Dozentin an der team-fAkademie und in einer psychologischen Beratungsinstitution für Paare, Einzelne und Familien tätig. Gemeinsam mit ihrem Mann leitet sie die Paararbeit der Stadtkirche 316. www.schneider-ira.com
Er hat sie lieb, schätzt sie wert und segnet sie!
Dies soll in der Krabbelgruppe bzw. im Spielkreis besonders zum Ausdruck kommen. Krabbelgruppen sind darum ein Gewinn für Kinder und Eltern, aber auch für die Gemeinde, weil sie zu einem Ort wird, an dem Menschen Gottes Liebe erleben. Wie Krabbelgruppen in die Gemeinde eingebunden werden können und was für die Planung und Durchführung von Programmen wichtig ist, erklären die Autorinnen beispielhaft in diesem Buch.
Mit den Stundenentwürfen im Buch entdecken Krabbelkinder
– ihre Sinne
– die Jahreszeiten
– Geschichten aus dem Alten und Neuen Testament – Psalmengebete
– besondere Feste



• Verbindung zwischen Theorie und Praxis
• Mit 44 ausgearbeiteten Programmentwürfen


• Für alle, die Gottes Wertschätzung an Kinder und Eltern weitergeben möchten


Petra Schünemann ist Erzieherin und Gemeindediakonin und lebt mit ihrem Mann und ihren vier Töchtern in Marburg.
Alexandra Schüßler ist Grundschullehrerin und Fortbildungsleiterin im Bereich Religionspädagogik. Sie lebt mit ihrem Mann, ihren zwei Söhnen und einer Tochter in Marburg.
Petra Schünemann (Hrsg.)
Alexandra Schüßler (Hrsg.) Krabbelkinder entdecken Gottes Welt 44 praxiserprobte Stundenentwürfe für Gruppen im Krabbel- und Kleinkindalter Nr. 182.644, € 17,–€[A] 17,50/CHF 23,–* Paperback 14,8 × 21 cm, 160 S. ISBN 978-3-87092-644-1
Erscheint: Juni 2024




Die Konfi-Freizeit, ICH GLAUB’S, Truestory, das Event oder der Konfiunterricht sind vorbei. Doch was jetzt? Du willst mit Jesus durchstarten, aber wie kannst du Nachfolge erleben? Die 53 Ideen in diesem Buch fordern dich heraus, die Beziehung zu Gott einzugehen. Hier darfst du Gott persönlich erleben, Neues kennenlernen, Dinge ausprobieren, hinterfragen und deinen persönlichen Weg finden hinein in die Jesus-Nachfolge.
• Für Konfirmanden, Jesus-Fans und Neustarter im Glauben ab ca. 14 Jahren
• Ein Buch zum Mitmachen und um kreativ zu werden
• Wenig Text, viel Freiraum zum Gestalten
Tobias Liebmann, Ingo Müller, Martin Schott, Mire Tölgyesi (Illustr.)
Follow up
53 Ideen für deinen Start mit Jesus Nr. 182.645, € 7,95
€[A] 8,20/CHF 10,70
Paperback
10,5 × 14,8 cm, 96 S.
ISBN 978-3-87092-645-8
Erscheint: September 2024



Tobias Liebmann arbeitet als Bundessekretär für Bildung, Beratung und Begleitung beim CVJM Westbund und wohnt mit seiner Familie in Bad Oeynhausen. Ingo Müller arbeitet als Referent für Teenager und Team-EC beim Deutschen Jugendverband »Entschieden für Christus« (EC) e. V. und wohnt in der Nähe von Kassel. Martin Schott arbeitet in den Bereichen Teenagerarbeit und Sport beim CVJM-Westbund. Er mag den BVB, Spiele, und wenn junge Menschen sich im Glauben herausfordern lassen.









Die Landkarte der Gefühle ist der perfekte Begleiter für Einzelgespräche (z. B. Mentoring) und Gruppenprozesse (z. B. in Gemeinden). Gefühle und Eindrücke werden hier in Form von bekannten und alltäglichen Bildern und Begri en dargestellt. So werden Assoziationen geweckt, Empfindungen können leichter benannt und Veränderungen dargestellt werden.
Lieferumfang:
Landkarte DIN A2, gefaltet auf DIN lang, beidseitig bedruckt, einmal mit dazugehörigen Begriffen und einmal ohne.
One2One
»Die Mentoring-Methodenbox« Nr. 184.587
















































Ebenfalls sehr hilfreich bei Einzelgesprächen und Gruppenprozessen
• Hilfe zum Ausdrücken der eigenen Gefühle





zweiseitig bedruckt







Rückseite ohne Begriffe, zum Selbergestalten
• Gleichermaßen geeignet für Einzelgespräche und Gruppenprozesse
• Faltbar und damit praktisch zum Mitnehmen

Mire Tölgyesi hat ihre Ausbildung zur Jugendreferentin am CVJMKolleg absolviert und später an der Theologischen Hochschule Reutlingen ihren Master gemacht. Als systemische Therapeutin und Organisationsentwicklerin ist sie vor allem im CVJM-Kontext unterwegs. Ihr vielseitiges Angebot findet man unter: www.oikos-Beratung.de
Mire Tölgyesi Emotion-Map Landkarte der Gefühle
Nr. 182.646, € 12,95*
€[A] 13,30*/CHF 19,30*
59,4 × 42 cm
4-farbige Landkarte DIN A2
ISBN 978-3-87092-646-5
Erscheint: Juli 2024




Kanada, 1905. Adelaide hätte nie gedacht, drei Freundinnen in ihrer neuen Heimat zu finden, die wie Schwestern für sie sind. Sie versprechen sich, für immer zusammenzuhalten – doch dann hebt der Erste Weltkrieg ihre Welt aus den Angeln und der deutschamerikanische Mann, den Adelaide und Dorothy lieben, wird unbegründet verdächtigt. Eine schreckliche Explosion reißt die Schwesternschaft schließlich unwiderruflich auseinander. Jahre später erhält Rosaline einen Anruf von Dorothy, der Erinnerungen wachruft, die sie vergessen wollte. Erinnerungen an einen Mann, den sie einst liebte, an eine Schwesternschaft, die sie im Stich ließ, und an den Tag, an dem sie aufhörte, Adelaide zu sein.
• Ein historischer Roman im Kontext der Halifax-Explosion 1917 an der kanadischen Ostküste
• Macht Mut, nicht aufzugeben, auch wenn es nicht so kommt, wie man es sich wünscht
• Zeigt auf, wie Vergebung und Ehrlichkeit Freundschaften retten können


schreibt Romane voller inspirierender Botschaften. Viele von ihnen haben Preise gewonnen. Wenn sie nicht auf Reisen ist, um für ihre Bücher zu recherchieren, verbringt sie gerne Zeit mit ihrer Familie. Sie lebt mit ihrem Mann, ihren erwachsenen Kindern, Enkelkindern und ihrem Hund Reilly in den USA.
cathygohlke.com
Sammelleseprobe
»Romane Herbst 2024« – 25er-Set
Nr. 950.126.002
»Dieser Roman hat mich tief berührt und daran erinnert, wie wertvoll meine eigenen Freundinen sind.«
LYNN AUSTIN, Bestsellerautorin
Lieferbar:












»Jede Seite war bis zum überraschenden Ende hin ein reiner Genuss.«
LYNN AUSTIN, Bestsellerautorin







Im modularen Paket »Romane« auf S. 54 enthalten
Cathy Gohlke, Heide Müller (Übersetz.) In Zeiten der Freundschaft Nr. 396.210, € 25,–€[A] 25,70/CHF 33,80* Gebunden, 13,5 × 21,5 cm, 400 S. ISBN 978-3-7751-6210-4
Erscheint: Juni 2024

















































































Tel Aviv 2015. Als die Konflikte in Jerusalem aufflammen und eine Welle der Gewalt durch das Land zieht, werden die Ideale von drei jungen Leuten erschüttert. Wael, ein Palästinenser, arbeitet illegal in Tel Aviv. Er ho t auf eine gemeinsame Zukunft mit seiner Verlobten, die er nicht heiraten darf, bis sein Haus in Bethlehem fertiggestellt ist. Yahav, eine Israelin, kehrt zurück in ihr Elternhaus, als ihre Beziehung zerbricht. Nienke, eine Christin, entdeckt erst allmählich die Spaltungen innerhalb der israelischen Gesellschaft – und was das für ihre Beziehung mit Yahavs Zwillingsbruder bedeutet. Sie alle müssen drastische Entscheidungen tre en, die ihr Leben für immer verändern werden.
• Ein Israel-Roman, den man nie wieder vergisst
• Mit tiefen Einblicken in das Alltagsleben und die heterogene Gesellschaft in Israel
• Legt den Fokus auf die Menschen hinter dem Nahostkonflikt
























ist in den Niederlanden geboren und hat über acht Jahre lang in Israel gelebt. Sie studierte »Geschichte des Mittleren Ostens und Afrika« in Tel Aviv und arbeitet in einer Non-Profit-Organisation in der Ukraine. Ihr Debüt schrieb sie mit siebzehn Jahren. Dies ist ihr dritter Roman.
Sammelleseprobe
»Romane Herbst 2024« – 25er-Set Nr. 950.126.002





»Eline Rosenhart nimmt die kleinsten Facetten des Landes wahr und präsentiert sie den Lesern – als wäre man mittendrin.«
ASSAF ZEEVI, Autor, Reiseleiter, Referent und Podcaster
»Dieser Roman ist eine Chance, unseren Horizont zu erweitern. Er fordert uns heraus und sprengt so manche gedankliche Grenze.«
TABEA HALBMEYER, Lektorin
Im modularen Paket »Romane« auf S. 54 enthalten
Eline Rosenhart, Martina Merckel-Braun (Übersetz.)
Mein Land, mein Leben
Ein Israel-Roman Nr. 396.206, € 23,–€[A] 23,70/CHF 31,10*
Gebunden, 13,5 × 21,5 cm, 368 S. ISBN 978-3-7751-6206-7 Erscheint: Juli 2024

Modulares
MengeAuswahl Positionen
In Zeiten der Freundschaft (396.210)
Mein Land, mein Leben (396.206)
Das Versprechen eines neuen Tages (821.046)




Rebellin mit Herz (821.056)
Ein Lied für den Feind (396.193)
Ihre individuelle Auswahl bringt bei einer Mindest-Abnahme-Menge satte Rabatte!
Ihre Auswahl
Ihre Menge
Mit Ihrer Auswahl erreichen Sie folgende Paketstufe 5 Positionen 4 Positionen
Stückzahl ermitteln
Erfüllen Sie die Mindest-Abnahme-Menge 25 Stück 15 Stück

Ihr erreichter Rabatt auf die Bestellung 48%46% GroßKlein
Modulare Pakete erhalten Sie nur über Ihren Vertreter oder bei telefonischer Bestellung über unsere Auftragsbearbeitung.
Volles RR für 18 Monate, Auslieferung: sobald die Titel erscheinen

Wenn Sie das Verhältnis von Positionen und Stück erreichen –mehr geht natürlich immer –, erhalten Sie satte Rabatte!


SAMMELLESEPROBE
»Romane Herbst 2024«
– 25er-Set
Nr. 950.126.002













Dieses Paket finden Sie auch in der Gerth-MedienVorschau auf S. 108/109















































































































»Ich hatte keine Angst mehr.




Niemand würde mich je wieder verletzen.«
Vom Täter zum Wohltäter –Wie Gottes Liebe alles veränderte Mick Fleming war ein aufgeweckter und fröhlicher Junge, bis ein Ereignis sein Leben für immer veränderte: Er wurde vergewaltigt. Als er sich gerade seinen Eltern anvertrauen wollte, kam die schreckliche Nachricht, dass seine Schwester plötzlich gestorben war. So behielt er sein Geheimnis für sich, weinte 30 Jahre lang nicht mehr, verbarg seinen Schmerz in Alkohol und Drogen. Er arbeitete als berüchtigter Drogendealer und Schuldeintreiber – bis zu dem Tag, an dem eine O enbarung des Glaubens seine Welt auf den Kopf stellte und er sich völlig überwältigt von der Liebe Gottes fand. Diese Liebe sollte sein Leben für immer verändern ...
• Öffnet die Augen für die außergewöhnliche Kraft der Vergebung
• Vermittelt Hoffnung für Menschen, die mit Sucht, Trauer oder Armut kämpfen
• Mit einem Vorwort von Prinz William






 Mick Fleming
Mick Fleming





(Jg. 1966) ist der leitende Pastor von Church on the Street (COTS) in seiner Heimatstadt Burnley, England. COTS ist eine christliche Gemeinschaft, die sich der Hilfe für andere verschrieben hat, insbesondere für Menschen, die obdachlos sind, mit Süchten zu kämpfen haben oder an der Armutsgrenze leben. Seit 2020 ist er mit Sarah verheiratet.
Sammelleseprobe
»Biografien Herbst 2024« – 25er-Set Nr. 950.126.003
Plakat A3
»Flemming: Schonungslose Gnade« Nr. 950.127.001
















»Es ist unmöglich, die Church on the Street zu besuchen, ohne tief bewegt zu sein. Diese Organisation hat es sich zum Ziel gesetzt, Menschen in Not zu helfen.«
Seine königliche Hoheit William, Herzog von Cambridge
Vorteilsangebot »Schonungslose Gnade«
Bestell-Nr. Buch 390.000.409 Groß*Klein 10× 5×Schonungslose Gnade (396.207) 48%46%Rabatt
104,– €D 54,– €DNetto-Einkaufswert 200,– €D 100,– €DGesamt-Brutto-Verkaufswert
Volles RR für 18 Monate, Auslieferung: August 2024
* Bei der Bestellung von zwei kleinen Vorteilsangeboten erhalten Sie 48 % Rabatt.
Mick Fleming, Dagmar Schulzki (Übersetz.) Schonungslose Gnade Meine Geschichte von Täuschung, Erlösung und der Kraft der Vergebung Nr. 396.207, € 20,–€[A] 20,60/CHF 27,–* Gebunden, 13,5 × 21,5 cm, 208 S. mit Schutzumschlag und 8-seitigem Bildteil ISBN 978-3-7751-6207-4
Erscheint: August 2024





• Aus der Sucht in die Freiheit, aus der Belanglosigkeit in die Bedeutsamkeit
• Ein erfrischendes Zeugnis: Gott kann jeden gebrauchen!
• Ermutigt und bringt Hoffnung und Perspektive
Uwe Heimowski, Hauke Burgarth
Mit dem Leben spielt man nicht Wie der Glaube mich aus der Sucht befreite und ich eine zweite Chance bekam
Nr. 396.238, € 20,–
€[A] 20,60/CHF 27,–*
Gebunden, 13,5 × 21,5 cm, 240 S. mit 16-seitigem Bildteil
ISBN 978-3-7751-6238-8
Erscheint: Juli 2024
»Du bist wie dein Vater!« – Diesen Satz hört Uwe als Kind immer wieder von seiner Mutter. Sein Vater: ein Alkoholiker, gewalttätig, missbrauchend. So glaubt er schon früh, dass aus ihm nie etwas werden würde. Die Beziehungen zu seiner Familie sind desolat und zerbrochen. Auf der Suche nach Erfüllung sucht er an den falschen Stellen: im Alkohol und an Spielautomaten. Sein Leben gerät auf die schiefe Bahn und sinkt immer tiefer in Sucht, Ho nungslosigkeit und Verzweiflung. Doch am Tiefpunkt begegnet er Jesus und er erlebt, wie Gott ihm all das gibt, was er immer gesucht, aber nie gefunden hatte: Heimat, Ho nung und Zukunft. Und Berufung – denn mit Gott fängt das Leben erst so richtig an ...
Sammelleseprobe »Biografien Herbst 2024« – 25er-Set Nr. 950.126.003
»Autobiografien unterscheiden sich von Krimis dadurch, dass man weiß: Es wird gut ausgehen. Spannend ist diese hier trotzdem. Und berührend, erschütternd, befreiend. Weil Uwes Lebenslauf eine Art kontinuierliches Wunder ist.«
ANDREAS MALESSA, Radiojournalist, Theologe, Buchautor

Uwe Heimowski (Jg. 1964) lebt in Gera. Er ist verheiratet mit Christine, sie haben fünf Kinder. Der Erzieher und Theologe war 15 Jahre Pastor der EfG Gera und von 2016–2022 politischer Beauftragter der Evangelischen Allianz in Deutschland. Seit Mai 2023 ist er Vorstand von Tearfund Deutschland, einem christlichhumanitären Hilfswerk.
Klaus Heizmann erzählt in seinem Buch Episoden aus seinem bewegten Leben: von seinen Anfängen als Musiker, seinen Erfolgen und Fehlern, von Hochzeiten und Verspielern. Er berichtet von Kriegserlebnissen, Freundschaften, Bühnenstücken und von der prägenden Wirkung der Musik im Alltag. Dabei gibt er tiefergehende Einblicke in die herzensverändernde Kraft der Glaubenslieder. Sein Blick durch die Brille von Musik und Glauben lädt die Leser ein, Rückschau zu halten, sich mit ihm zu erinnern, an das, was Gott Gutes bewirkt hat –durchaus zum Schmunzeln. Und es lässt einen so manche alte Melodie aus der Feder dieses Tausendsassas fröhlich auf den Lippen trällern.
Sammelleseprobe
»Biografien Herbst 2024« – 25er-Set Nr. 950.126.003
Reinhören
Musik von Klaus Heizmann auf Spotify entdecken





• Interessante Einblicke und humorvolle Anekdoten aus dem Leben des bekannten Komponisten
• Eine Sammlung von »geistlichen Schätzen«: ein Buch, das zum Erinnern einlädt
• Das Leben und Werk von Klaus Heizmann hat viele Christen entscheidend geprägt

Klaus Heizmann (Jg. 1944) stammt aus Haan in NordrheinWestfalen und ist Wegbereiter des Neuen Geistlichen Liedes. Er liebt Musik leidenschaftlich und ist seit seinem evangelischen Kirchenmusikstudium in Deutschland und Amerika als Chor- und Orchesterdirigent, Komponist und Musikproduzent tätig.
Klaus Heizmann
Mein Leben in Dur und Moll Harmonien zwischen Himmel und Erde Nr. 396.239, € 18,–€[A] 18,60/CHF 24,30* Gebunden, 13,5 × 21,5 cm160 S. mit 16-seitigem Bildteil
ISBN 978-3-7751-6239-5
Erscheint: August 2024



















Es ist der 15. Juli 2021. Vivien, ihr Mann Harry und ihre sieben Monate alte Tochter sind unterwegs zum Haus der Schwiegereltern im Landkreis Ahrweiler. Dass sich dort in der Nacht eine der schlimmsten Naturkatastrophen in Deutschland ereignete, wissen sie noch nicht. Ebenso wenig, dass weder die Schwiegereltern noch der jüngere Schwager diese Nacht überlebten. Erst mehrere Wochen später werden die Körper von Hans und Ella, Harrys Eltern, gefunden. Sein Bruder Franky bleibt vermisst. Vivien Neufeld berichtet aus ihrer Sicht. Sie schreibt über ihre Trauer und darüber, wie sie all das dennoch überstehen. Am Ende findet sie für sich eine Antwort darauf, was bleibt, auch wenn alles andere vergeht.


• Ein authentischer und mutmachender Augenzeugenbericht
• Spendet Hoffnung und Trost: Gottes Handschrift lässt sich immer finden
• Für Menschen, die Interesse an den Ereignissen rund um die Flut im Ahrtal haben














 Vivien Neufeld
Vivien Neufeld
(Jg. 1993) wuchs im Ahrtal auf. Sie arbeitet bei einem großen deutschen Unternehmen in Bonn, wo sie mit ihrem Mann und den gemeinsamen Töchtern lebt. Sie liebt es zu reisen, Neues zu sehen und Schönheit in den kleinen Dingen zu entdecken.
vonwort.de
Sammelleseprobe »Biografien Herbst 2024« – 25er-Set Nr. 950.126.003






»42.000 Menschen waren im Ahrtal von der Flut im Juli 2021 betroffen. Eine äußere und vor allem innere Katastrophe. Dieses Buch gewährt tiefe Einblicke in das Schicksal einer Familie. So persönlich und ehrlich erzählt, so ergreifend und bewegend. Vivien beschönigt nichts. Und Hoffnung trägt wirklich.«
SASCHA NEUDORF, Fluthelfer und Leiter des Hoffnungswerk e. V.
»Vivien erzählt von ihrem Erleben nach der Flut. Von ihrem Umgang mit Trauer, Wut, Unverständnis und auch Frieden. Ein bemerkenswertes Buch, das mich tief beeindruckt hat.«
ELKE JANSSEN, Systemische Beraterin und Buchautorin





Vivien Neufeld
Der Tag, an dem der Sommer zu Ende ging Die Flutkatastrophe im Ahrtal und unsere Familie Nr. 396.237, € 18,–€[A] 18,60/CHF 24,30* Klappenbroschur, 13,5 × 21,5 cm, 224 S. ISBN 978-3–7751-6237-1
Erscheint: Juli 2024























Oskar König
24 x Weihnachten neu erleben
Nr. 226.942, € 9,95
€[A] 10,30/CHF 13,40*
ISBN 978-3-417-26942-0













Todd Burpo, Lynn Vincent
Den Himmel gibt’s echt
Die erstaunlichen Erlebnisse eines Jungen zwischen Leben und Tod
Nr. 395.278, € 17,–
€[A] 17,50/CHF 23,–*
ISBN 978-3-7751-5278-5







Esther Ahmad, Craig Borlase
Die Glaubenskriegerin
Ich kämpfte um Allahs Aufmerksamkeit und fand Gottes liebevollen Blick

Nr. 395.974, € 23,–
€[A] 23,70/CHF 31,10*
ISBN 978-3-7751-5974-6














Assaf Zeevi
Lass das Land erzählen
Nr. 396.075, € 23,–





















Maria Prean-Bruni, Daniel Exler
Ab durch die Decke – hinein ins Reich Gottes
Nr. 227.000.049, € 20,–
€[A] 20,60/CHF 27,–*
ISBN 978-3-417-00049-8



Eine Reise durch das biblische Israel
€[A] 23,70/CHF 31,10*

ISBN 978-3-7751-6075-9
















John Mark Comer
Das Ende der Rastlosigkeit
Mach Schluss mit allem, was dich hetzt –und komm bei Gott an
Nr. 227.000.039, € 23,–
€[A] 23,70/CHF 31,10*
ISBN 978-3-417-00039-9









MengeAuswahl Positionen

Sein Wort – meine Welt. Lederausgabe (227.002.042)





Sein Wort – meine Welt. Kunstlederausgabe (227.002.041)
Sein Wort – meine Welt (227.002.040)

Ihre Auswahl


Ihre individuelle Auswahl bringt bei einer Mindest-Abnahme-Menge satte Rabatte!


Ihre Menge

Stückzahl ermitteln

Mit Ihrer Auswahl erreichen Sie folgende Paketstufe 3 Positionen 2 Positionen

Erfüllen Sie die Mindest-Abnahme-Menge 7 Stück 4 Stück






Wenn Sie das Verhältnis von Positionen und Stück erreichen –mehr geht natürlich immer –, erhalten Sie satte Rabatte!



Ihr erreichter Rabatt auf die Bestellung 38%35% GroßKlein

Volles RR für 18 Monate, Auslieferung: sobald die Titel erscheinen


Modulare Pakete erhalten Sie nur über Ihren Vertreter oder bei telefonischer Bestellung über unsere Auftragsbearbeitung.











PLAKAT A3
»Sein Wort – meine Welt« Nr. 950.128.001






PLAKAT DIN A1 LANG
»Übersicht Bibelausgaben« Nr. 950.358.001



ANZEIGEN
Aufatmen
Christsein heute DRAN
Faszination Bibel Hauskreismagazin


»Bibelübersetzungen« – 25er-Set Nr. 950.403.001





Jetzt in neuem Gewand: Die zeitgemäße Studienbibel für authentisches Christsein

























Sein Wort – meine Welt.
Lederausgabe
227.002.042






Sein Wort – meine Welt. Kunstlederausgabe
227.002.041



















SANDRO GÖPFERT, 3E echt. evangelisch. engagiert. Das Ideenmagazin für die Kirche.


»[...] Diese Studienbibel ist reichhaltige Fundgrube, wertvolles Nachschlagewerk und eine echte Hilfe für die eigene Stille Zeit, das gemeinsame Bibellesen im Hauskreis oder die Vorbereitung von Andachten. «


















Sein Wort – meine Welt. 227.002.040








JÜRGEN THIELMANN, Idea Spektrum Spezial Advent & Weihnachten



»[...] Dieses Buch wird jedem Bibelleser helfen, sein Christsein heute zu leben. «

»[...] Ein empfehlenswertes, gelungenes Werk. « KARL-HEINZ VANHEIDEN, Bibel und Gemeinde



















• Mit Hunderten farbigen Karten, Diagrammen und Übersichten
• Zeitgemäßes Bibelstudium
• Edler Einband aus Echtleder
Im modularen Paket »Sein Wort – meine Welt« auf S. 66 enthalten
• Wie können wir die Bibel heute leben?
• Langlebiger Einband aus Kunstleder
Im modularen Paket »Sein Wort – meine Welt« auf S. 66 enthalten

Sein Wort – meine Welt. Lederausgabe
Die Studienbibel für das 21. Jahrhundert
Nr. 227.002.042, € 99,–



€[A] 101,80/CHF 133,70* Leder, 16 × 23,5 cm, 2144 S. 4-farbige Innengestaltung, Textstand 32
ISBN 978-3-417-02042-7
Erscheint: April 2024


Sein Wort – meine Welt. Kunstlederausgabe
Die Studienbibel für das 21. Jahrhundert
Nr. 227.002.041, € 69,–

€[A] 71,–/CHF 93,20* Kunstleder, 16 × 23,5 cm, 2144 S. 4-farbige Innengestaltung, Textstand 32
ISBN 978-3-417-02041-0
Erscheint: April 2024








Die einzigartige Studienbibel »Sein Wort –meine Welt« zeigt, wie authentisches Christsein in der heutigen Gesellschaft aussehen kann. Die Kommentare und Erläuterungen greifen die vielfältigen Bezüge des Alltags auf: Beruf, Familie, Kultur, Politik, ethische Entscheidungen, Umgang mit Geld, persönliche Lebensführung u. v. m. Dabei garantiert der Text der Elberfelder Bibel eine exakte und zuverlässige Übersetzung. Die zahlreichen Kommentare werden ergänzt durch Personenporträts, ein Verzeichnis biblischer Berufe, Landkarten und Diagramme sowie eine durchgängig vierfarbige Gestaltung.










• Greift moderne Fragestellungen auf


• Erklärt kulturelle, historische und theologische Hintergründe
• Mit der genauen Elberfelder Übersetzung





















































Im modularen Paket »Sein Wort – meine Welt« auf S. 66 enthalten
Sein Wort – meine Welt






















Die Studienbibel für das 21. Jahrhundert Nr. 227.002.040, € 52,–€[A] 53,50/CHF 70,20* Gebunden, 16 × 23,5 cm, 2144 S. 4-farbige Innengestaltung, Textstand 32


ISBN 978-3-417-02040-3

Erscheint: April 2024





• Gut lesbares Druckbild
• Hochwertiger Umschlag aus flexiblem Kunstleder

Die alltagsnahe Übersetzung der »Neues Leben«-Bibel vermittelt durch die große, gut lesbare Schrift und das einspaltige Druckbild einen ruhigen Eindruck und ermöglicht einen guten Lesefluss. Eine lesefreundliche Bibelausgabe in großer Schrift in hochwertigem Kunstlederumschlag.


• Für Leser, die große Schrift bevorzugen
Lieferbar:
Neues Leben. Die Bibel, große Schrift, Kunstleder Nr. 227.002.045, € 49,–€[A] 50,40/CHF 66,20* Kunstleder, 14,5 × 21,5 cm, 2064 S. inkl. 16 Seiten Kartenmaterial, 2 Lesebändchen
ISBN 978-3-417-02045-8
Erscheint: Juni 2024




Nr. 225.818



















DerSchöpfungsbericht AmAnfangschufGottdenHimmelunddieErde. wüstundöde,finsterwaresüberdenWassern.UndderGeistGottes schwebteüberderWasserfläche. * DasprachGott: stehen!«,undesentstandLicht. * UndGottsah,dassdasLichtgut war.DanntrennteerdasLichtvonderFinsternis. Licht »Tag« unddieFinsternis »Nacht«.EswurdeAbendundMorgen:derersteTag.
* UndGottsprach: »EssollRaumzwischendenWassernentstehen, derdieWasservoneinandertrennt.« * Undsogeschahes.Gottschuf diesenRaum,umdieWasseroberhalbundunterhalbdiesesRaumes zutrennen. * UndGottnanntedenRaum » AbendundMorgen:derzweiteTag.

* UndGottsprach: »DieWasserunterdemHimmelsollensich aneinemOrtsammeln,damittrockenerBodenzumVorschein kommt. Undsogeschahes. GottnanntedentrockenenBoden .UndGottsah,dassesgutwar. AufderErdesollGraswachsenundsiesollPflanzenhervorbringen,dieSamentragen,undBäumevollerunterschiedUndsogeschahes.




Beispiel Schriftbild Maßstab 1:1


Wurde die Erde wirklich in sieben Tagen erscha en? Ist der Schöpfungsbericht »nur« theologisch zu verstehen oder hat er auch eine geschichtliche Bedeutung? In bewährter Weise geht der Mathematiker und BestsellerAutor John Lennox auf Fragen ein, die viele an den Schöpfungsbericht der Bibel stellen. Er bringt den biblischen Text mit den neuesten wissenschaftlichen Forschungsergebnissen ins Gespräch und zeigt einmal mehr, dass er die biblischen Texte ernst nimmt und diese zugleich als Ergänzung zu wissenschaftlichen Erkenntnissen erachtet.



AmAnfangschufGottdenHimmelunddieErde. wüstundöde,finsterwaresüberdenWassern.UndderGeistGottes
DasprachGott: UndGottsah,dassdasLichtgut war.DanntrennteerdasLichtvonderFinsternis. .EswurdeAbendundMor-
EssollRaumzwischendenWassernentstehen, Undsogeschahes.Gottschuf diesenRaum,umdieWasseroberhalbundunterhalbdiesesRaumes Himmel


• Endlich wieder da und jetzt aktualisiert und erweitert!
• Scharfsinnige Antworten auf aktuelle Fragestellung
DieWasserunterdemHimmelsollensich aneinemOrtsammeln,damittrockenerBodenzumVorschein GottnanntedentrockenenBoden .UndGottsah,dassesgutwar. AufderErdesollGraswachsenundsiesollPflanzenhervorbringen,dieSamentragen,undBäumevollerunterschiedUndsogeschahes.
• Bestseller-Autor mit großer Fangemeinde in Deutschland

John Lennox (geb. 1943) ist emeritierter Mathematikprofessor an der Universität Oxford und Autor zahlreicher Bücher zum Verhältnis von Glaube, Ethik und Wissenschaft. Durch Vorträge auf Tagungen und Konferenzen ist er auch in Deutschland bekannt.
John Lennox Sieben Tage, das Universum und Gott Was Wissenschaft und Bibel über den Ursprung der Welt sagen
Nr. 224.186, € 20,–€[A] 20,60/CHF 27,–* Gebunden, 14 × 21,5 cm, 176 S., 1-farbig
ISBN 978-3-417-24186-0
Erscheint: September 2024

Wenn ich den Himmel betrachte und das Werk deiner Hände sehe –
wie klein und unbedeutend ist da der Mensch und doch denkst du an ihn und sorgst für ihn!
für Ihren Verkaufserfolg:






POSTKARTE DVD-FORMAT
»Psalmen – Motiv 1« – 25er-Set Nr. 950.134.001
»Psalmen – Motiv 2« – 25er-Set Nr. 950.134.002



»Psalmen – Motiv 3« –25er-Set Nr. 950.134.003
ANZEIGEN
Spotify Ad Kampagne
DRAN
Family
Hauskreismagazin
Faszination Bibel
Spezial
Joyce teensmag
PRESSE/PR
Social-Media-Kampagne

»Wenn mein Herz schwer ist und mir Worte fehlen, dann schaue ich in die Psalmen. Sie heben meinen Blick wieder auf und richten meine Aufmerksamkeit auf das Wesentliche. Sie sind nicht nur schöne Worte –sie sind kunstvoll geschrieben und so verdienen sie auch ein kunstvolles Außen.«
MAGGY MELZER, visuelle Brand-Expertin im Bereich Brand- und Produktfotografie und Teil von Wortdesign


»Ich freue mich auf das fertige Buch und darauf, die Psalmen mit allen Sinnen noch einmal neu zu entdecken. Als Kind habe ich Kerzen aus Dänemark gesammelt und mich über die besonderen Formen und Farben gefreut. Die Psalmen jetzt in diesem ansprechenden Gewand entstehen zu lassen, erinnert mich ein wenig zurück an diese Kindheitstage und weckt in mir den Wunsch, eine ganze Sammlung davon zu haben.«

STENNIE (Stefanie Krel), vertreibt unter ihrem Label »STENNIE STUDIO« christliche Produkte mit Tiefgang und Schönheit und ist Teil von Wortdesign

»Ich kann es kaum erwarten, dieses Buch in den Händen zu halten und mein Zuhause damit zu dekorieren.
Gottes Wort, die Bibel, visuell sichtbar zu machen, ist meine Passion. Und gerade die Psalmen sind ein Kunstwerk in sich, voller Schönheit und Tiefgang.«
NELLY VOTH, Grafikdesignerin (u. a. »GOD IS A DESIGNER«) und Teil von Wortdesign





Für den Chorleiter: Ein Psalm der Nachkommen Korachs, mit Streichinstrumenten zu begleiten.
2 Wie herrlich sind deine Wohnungen, allmächtiger HERR.
3 Ich sehne mich, ja ich vergehe vor Sehnsucht, die Vorhöfe des HERRN zu betreten, wo ich den lebendigen Gott mit frohem Herzen anbeten will.
4 Selbst ein Vogel findet dort ein Heim, und die Schwalben bauen ihr Nest und ziehen ihre Jungen auf, nahe bei deinen Altären, allmächtiger HERR, mein Gott und König!
5 Wie glücklich sind die, die in deinem Hause wohnen dürfen, sie werden dich jederzeit loben. Musik
6 Glücklich sind die Menschen, die in dir ihre Stärke finden und von Herzen dir nachfolgen.
7 Wenn sie das Tal der Tränen durchqueren, wird es ihnen zu einem Ort erfrischender Quellen und der Frühregen bedeckt es mit Segen.
8 So bekommen sie immer wieder neue Kraft und erscheinen in Jerusalem vor Gott.
9 HERR, allmächtiger Gott, vernimm mein Gebet und erhöre mich, Gott Israels. Musik
10 Gott, schau den König, unseren Beschützer, gnädig an. Hab Erbarmen mit ihm, den du auserwählt hast!
11 HERR, ein einziger Tag in deinen Vorhöfen ist besser als sonst tausend! Lieber möchte ich Torhüter im Haus meines Gottes sein,


„GLÜCKLICH SIND DIE MENSCHEN, DIE IN DIR IHRE STÄRKE FINDEN UND VON HERZEN DIR NACHFOLGEN.“
»Ich strecke meine Hände nach dir aus. Ich sehne mich nach dir, wie dürres Land nach Regen dürstet.«
Psalm 143,6
Das tiefe Wesen der Psalmen in berührendes Design eingebettet Die Psalmen o enbaren das Herz und die Seele des Menschen. Hier findet sich die ganze Bandbreite menschlicher Erfahrungen und Gefühle. In tiefster Verzweiflung schreien die Psalmisten zu Gott, und singen gleichzeitig die schönsten Lieder ihm zur Ehre. Ehrlich, kraftvoll und immer voller Tiefgang. Dieses Co ee-Table-Book bietet einen neuen Zugang zu biblischen Texten über ein schönes Design mit atmosphärischen Fotos, die den Inhalt der Verse sanft unterstreichen. So haben die Psalmen Raum, um zu wirken und ins Leben hineinzusprechen.
Diese Bibelausgabe schmückt auf stilvolle Art die Wohnung und bringt Gottes Wort mitten ins Leben hinein.
• Gestaltet von drei bekannten Influencerinnen mit großer Reichweite
• Neuer Zugang zu Bibeltexten übers Design
• Die Bibel, die man gerne offen auf dem Wohnzimmertisch liegen lässt


Wortdesign Studio
Wir sind Stennie, Maggy Melzer und Nelly Voth und uns verbindet die Liebe zu Gottes Wort, Schönheit und Design. Wir glauben, dass Gott der Ursprung aller Kreativität ist. Sein Wort ist ein Kunstwerk und mit unserer Gestaltung wollen wir ihm als Schöpfer Dank und Ehre geben. Wir träumen davon, dass die Bibel nicht als verstaubtes Buch im Regal bleibt, sondern sichtbar wird als Co ee-Table-Book. Unser Wunsch ist es, dass alle Menschen die Fülle und Schönheit dieses Buches genießen.






Komplettes Buch der Psalmen
Vorteilsangebot »Psalmen«
Bestell-Nr. Buch 220.000.401
Groß*Klein
10× 5×Psalmen (227.002.043) 40%35%Rabatt
145,60 €D 75,60 €DNetto-Einkaufswert 280,– €D 140,– €DGesamt-Brutto-Verkaufswert
Volles RR für 18 Monate, Auslieferung: August 2024
* Bei der Bestellung von zwei kleinen Vorteilsangeboten erhalten Sie 48 % Rabatt.
Wortdesign Studio Psalmen
Ein Buch voller Schönheit, Weisheit und Ho nung
Nr. 227.002.043, € 28,–€[A] 28,80/CHF 37,80* Gebunden, 19 × 26 cm, 192 S. ISBN 978-3-417-02043-4 Erscheint: September 2024





Was bedeutete der Text ursprünglich? Und was bedeutet er für heute?
Um die Schätze biblischer Aussagen zu entdecken, lohnt es sich, genauer hinzuschauen. Was steht wirklich im Bibeltext? Was meinte er, als er geschrieben wurde? Und was heißt das für uns heute? Dafür stellen Helge Stadelmann und Thomas Richter geeignete Werkzeuge vor, um in zehn Schritten den Bibeltext wahrzunehmen, zu verstehen und am Ende so aufzubereiten, dass man ihn auslegen und anderen erklären kann.
Mit konkreten Beispielen und praxisnahen Ratschlägen schulen sie den Blick für Bibeltexte und deren Anwendung in der Praxis. Am Ende steht eine fundierte Auslegung, die das Wort Gottes tief durchdringt und die Schätze biblischer Wahrheit aufschließt.
• Wie legen wir die Bibel aus, wie verstehen wir sie, wie können andere sie verstehen?
• Langjährig etabliertes Arbeitsbuch mit praxisnaher Methode
• Bereits über 10.000 verkaufte Exemplare
Helge Stadelmann, Thomas Richter
Bibelauslegung praktisch
In zehn Schritten den Text verstehen
Nr. 224.188, € 18,–
€[A] 18,60/CHF 24,30*
Paperback, 14 × 21,5 cm, 200 S.
ISBN 978-3-417-24188-4
Erscheint: August 2024


Helge Stadelmann (Jg. 1952) ist Altrektor der FTH Gießen und dort auch Seniorprofessor für Praktische Theologie. Er ist beheimatet im BEFG und in der Theologie des Pietismus. Er ist verheiratet und hat vier erwachsene Kinder.
Thomas Richter (M. A.) (Jg. 1966) ist Studienleiter und Dozent für Altes und Neues Testament am BibelStudienKolleg (BSK) Ostfildern bei Stuttgart.
Die Glaubwürdigkeit der Bibel wird immer wieder angezweifelt. Erstaunlicherweise sind einige der stärksten Befürworter der historischen Genauigkeit der Bibel gar keine Christen, sondern Wissenschaftler, die die archäologische Beweislage für sich sprechen lassen. Thomas Tribelhorn hat nach intensivem Studium in Israel Fakten gesammelt, welche die historische Genauigkeit der Bibel beweisen. Er zeigt auf, dass Behauptungen gegen die Glaubwürdigkeit der Bibel auf Verdrehungen der Beweislage beruhen.



• Ermutigung, an der Bibel festzuhalten
• Für alle, die durch Bibelkritik im Glauben verunsichert sind
• Faktenbasierte, schlüssige Verteidigung der Bibel

Thomas B. Tribelhorn ist Dozent am St. Petersburg Theological Seminary. Er hat einen Doktortitel in Judaistik von der Netzer David International Jeschiva erhalten und besitzt einen Doktortitel in jüdisch-christlichen Studien. Er hat zahlreiche Studienreisen nach Israel, Ägypten und Jordanien geleitet.


Wieder lieferbar!
Thomas B. Tribelhorn
»Die Bibel ist ein Mythos« –muss ich das glauben? Fakten bewerten statt Gott begraben
Nr. 395.713, € 14,95
€[A] 15,40/CHF 20,20*
Gebunden, 14,5 × 21 cm, 304 S. ISBN 978-3-7751-5713-1
Wieder lieferbar

Unsere Erde ist eingebettet in einen grandiosen Kosmos. Seit Menschengedenken ist die Faszination am All und an fernen Welten ungebrochen. Norbert Pailer hat in diesem Buch erstaunliche astronomische Fakten und atemberaubende Bilder zusammengestellt. Sie liefern Eindrücke von unserer Erde bis hin zu den fernsten Ecken des Kosmos. Pailer macht den Leser auf beeindruckende Zusammenhänge aufmerksam und zeigt, wie beim Blick zum Himmel die Spuren des Schöpfers erkennbar werden.
• Beeindruckende Weltraumbilder
• Faszinierende Fakten
• Bekannter Autor
Wieder lieferbar!
Norbert Pailer
Licht.Welten
Spurensuche eines Astrophysikers
Nr. 396.244, € 19,95
€[A] 20,60/CHF 26,90*
Gebunden, 17 × 24 cm, 240 S. ISBN 978-3-7751-6244-9
Wieder lieferbar

BACKLIST
Der vermessene Kosmos
Nr. 396.186, € 25,–
€[A] 25,40/CHF 33,80*

Norbert Pailer (Jg. 1949) studierte Kern- und Astrophysik in Heidelberg, ging zu einem Forschungsaufenthalt in die USA und war Programmleiter für satellitenbasierte Weltraumerkundung bei Airbus. Er publizierte mehrere erfolgreiche Bücher und wohnt mit seiner Frau bei Meersburg.
Eine sorgfältige, umfassende Erklärung des zweiten Chronikbuches, die genau in den Text schaut, den hebräischen Wortlaut übersetzt und historische Hintergrundinformationen gibt. Am Ende jedes Abschnitts stehen Predigtentwürfe und Anregungen für Bibelarbeiten. Die Reihe »Edition C Bibelkommentar, Altes Testament« ist wissenschaftlich fundiert, verständlich geschrieben und in der Gemeinde bewährt.



• Verbindung von Auslegung und Anwendung
• Allgemein verständlich und gemeindetauglich
• Für Pfarrer, Studierende und Mitarbeitende in Gemeinden

Walter Gisin
war elf Jahre lang Missionar in Peru und dann Pfarrer der Reformierten Kirche in der Schweiz. Aus seiner Feder stammt der Kommentar zum Hoseabuch wie auch der zum ersten Chronikbuch in der Edition-C-Reihe.


Walter Gisin
Das zweite Buch der Chronik (Edition C/AT/Band 16)
Nr. 225.092, € 29,–€[A] 29,90/CHF 39,20* Gebunden, 13,5 × 20,5 cm, 464 S. ISBN 978-3-417-25092-3
Erscheint: September 2024







Umfasst Buchstaben A–E
• Umfassendes Standardwerk zur Theologie
• Auf dem aktuellen Stand der Forschung
• Allgemein verständlich und fundiert
Der Preis beider Bände erhöht sich ab 1.7.2024 auf € 148,–/€[A] 152,20/CHF 199,80*
ELThG2 – Band 1
Evangelisches Lexikon für Theologie und Gemeinde, Neuausgabe
Nr. 226.801, € 128,–
€[A] 131,60/CHF 172,80* Gebunden, 17 × 25 cm, 1008 S. mit Schutzumschlag
ISBN 978-3-417-26801-0
Bereits lieferbar







Umfasst Buchstaben F–K
• Überkonfessionell und interdisziplinär
• Für Pastoren, Studierende, Mitarbeitende in Gemeinden
ELThG2 – Band 2
Evangelisches Lexikon für Theologie und Gemeinde, Neuausgabe
Nr. 226.802, € 128,–
€[A] 131,60/CHF 172,80* Gebunden, 17 × 25 cm, 1176 S. mit Schutzumschlag
ISBN 978-3-417-26802-7
Bereits lieferbar
Das ELThG2 ist ein vierbändiges, breit angelegtes Lexikon, das alle Felder der Theologie aus protestantischer Perspektive in ökumenischem Horizont darstellt. Es richtet sich an Theologen in Wissenschaft und Praxis, kirchliche Mitarbeiter und theologisch interessierte Gemeindeglieder. Seine besonderen Kennzeichen sind die überkonfessionelle Ausrichtung, der interdisziplinäre Ansatz (Teilartikel aus den Bereichen Biblische Theologie, Kirchengeschichte, Philosophie, Dogmatik, Ethik, Ökumene und Konfessionskunde, Missionswissenschaften, Soziologie sowie Praktische Theologie) und die Allgemeinverständlichkeit der Artikel.
Leseprobe
»Evangelisches Lexikon für Theologie und Gemeinde« Nr. 950.221.001



• Der dritte Band ist da!
• Mehr als 400 renommierte Autoren aus der protestantischen Welt und darüber hinaus
• Deckt alle Bereiche der Theologie ab



Umfasst Buchstaben L–R
ELThG² auch in der Subskription Band 1–4 erhältlich: €D 118,–Bei Bestellung der Art.-Nr. 226.848 wird eine Fortsetzung notiert und jeder weitere Band folgt automatisch zum günstigen Subskriptionspreis.
Heinzpeter Hempelmann, Uwe Swarat, Roland Gebauer, Wolfgang Heinrichs, Christoph Raedel, Peter Zimmerling (Hrsg.) ELThG2 – Band 3 Evangelisches Lexikon für Theologie und Gemeinde Nr. 226.803, € 148,–€[A] 152,20/CHF 199,80* Gebunden, 17 × 25 cm, 1056 S. mit Schutzumschlag ISBN 978-3-417-26803-4
Erscheint: September 2024






Das Thema Leitung und Leitungsverantwortung in Kirche und Gemeinde ist über Fälle von Machtmissbrauch und Leitungsversagen hinaus von grundsätzlicher Bedeutung. Denn was bedeutet es, im christlichen Kontext zu leiten – und was, sich leiten zu lassen? Welche Impulse und Korrektive bieten die biblischen Quellen für die Ausgestaltung von Leitung und Leitungsverantwortung in Landes- und Freikirchen oder christlichen Werken? Und wie sähe es aus, wenn Leitung als Hirtendienst ausgeübt wird? Diesen und anderen Fragen gehen die Beiträge dieses Jahrbuchs nach.
• Was bedeutet Leitung heute?
• Begründet eine eigene Meinung finden
• Für Theologen, Studierende, Pfarrer und Religionslehrer
Christoph Raedel (Hrsg.), Jürg Buchegger-Müller (Hrsg.)
Leitungsverantwortung in Kirche und Gemeinde
Jahrbuch für Theologische Studien 2024
Nr. 224.187, € 23,–
€[A] 23,70/CHF 31,10*
Broschiert, 15,5 × 23 cm, 360 S. ISBN 978-3-417-24187-7
Erscheint: September 2024


Professor Prof. Dr. Christoph Raedel hat ev. Theologie studiert, war Studienleiter und Dozent am CVJM-Kolleg und Professor für Ökumenische Theologie an der CVJMHochschule Kassel. Seit 2014 ist er Professor für Systematische Theologie und Theologiegeschichte an der FTH Gießen.
Dr. theol. Jürg Buchegger-Müller ist Pastor einer Schweizer Freien evangelischen Gemeinde und hat an verschiedenen akademischen theologischen Instituten in der Schweiz, in Belgien und in Österreich unterrichtet.












Mit diesem wunderschön gestalteten Bibelgri register kann man jede Bibelstelle schnell und einfach aufschlagen! Es zeigt an, wo jedes einzelne biblische Buch beginnt, sodass man einen guten Überblick hat. Enthalten sind auch Register-Reiter für Apokryphen und katholische Bibelbuch-Bezeichnungen, ebenso weitere Reiter für verschiedene Studienbibeln. Damit können diese Gri register in alle Bibeln mit den gängigen Übersetzungen eingeklebt werden.
Bereits über 86.000 verkaufte
Griffregister


• Wunderschöne Gestaltung
• Übersicht über die biblischen Bücher
Bibel-Gri register mit Folienprägung
Nr. 227.002.038, € 12,95*
€[A] 13,30*/CHF 19,30*
ISBN 978-3-417-02038-0
Erscheint: Juli 2024
Beiges Kraftpapier
• Hochwertiges Kraftpapier
• Für jede Bibelausgabe geeignet
Bibel-Gri register mit Kraftpapier
Nr. 227.002.039, € 12,95*
€[A] 13,30*/CHF 19,30*
ISBN 978-3-417-02039-7
Erscheint: Juli 2024















Elberfelder Studienbibel, Kunstleder, mit Sprachschlüssel und Handkonkordanz
Nr. 227.002.025, € 69,–
€[A] 71,–/CHF 93,20*
ISBN 978-3-417-02025-0




































Gerhard Maier (Hrsg.)
Edition C Bibelkommentar, Neues Testament, Gesamtausgabe im Schuber

Nr. 225.365, € 79,–
€[A] 81,30/CHF 106,70*
ISBN 978-3-417-25365-8











Neues Leben. Die Bibel – Sonderausgabe
Nr. 227.002.007, € 9,95
€[A] 10,30/CHF 13,40*
ISBN 978-3-417-02007-6


Genfer Studienbibel
Nr. 225.265, € 55,–
€[A] 56,60/CHF 74,30*



ISBN 978-3-417-25265-1

























Fritz Rienecker (Hrsg.), Gerhard Maier (Hrsg.), Ulrich Wendel (Hrsg.), Alexander Schick (Hrsg.) Lexikon zur Bibel Personen, Geschichte, Archäologie, Geografie und Theologie der Bibel Nr. 226.550, € 55,–
€[A] 56,60/CHF 74,30*
ISBN 978-3-417-26550-7

















Die Familienbibel Rätseln, basteln, singen. Mit Kindern die Bibel entdecken Nr. 225.394, € 29,–
€[A] 29,90/CHF 39,20*
ISBN 978-3-417-25394-8

















Begegnung fürs Leben, Motiv »Buch«
Die Studienbibel für jeden Tag
Nr. 227.002.021, € 52,–
€[A] 53,50/CHF 70,20*
ISBN 978-3-417-02021-2

















Begegnung fürs Leben, Motiv »Leuchtturm«
Nr. 227.002.020, € 52,–
€[A] 53,50/CHF 70,20*
ISBN 978-3-417-02020-5












Joyce Meyer













Begegnung fürs Leben, Kunstleder
Die Studienbibel für jeden Tag
Nr. 227.002.022, € 65,–
€[A] 66,90/CHF 87,80*

ISBN 978-3-417-02022-9

























Die Bibel mit Impulsen von Joyce Meyer, Kunstlederausgabe
Nr. 227.002.036, € 59,–
€[A] 60,70/CHF 79,70*
ISBN 978-3-417-02036-6





NLB Art Journaling Bibel



Neues Testament und Psalmen Neues Testament und Psalmen
Nr. 225.458, € 20,–
€[A] 20,60/CHF 27,–*
ISBN 978-3-417-25458-7












Begegnung fürs Leben, Leder
Die Studienbibel für jeden Tag
Nr. 227.002.023, € 85,–
€[A] 87,40/CHF 114,80*





ISBN 978-3-417-02023-6













NLB Art Journaling Bibel Gesamtausgabe
Nr. 225.373, € 45,–
€[A] 46,30/CHF 60,80*
ISBN 978-3-417-25373-3

Joyce Meyer
Die Bibel mit Impulsen von Joyce Meyer, Flexcover
Nr. 227.002.035, € 49,–
€[A] 50,40 /CHF 66,20*
ISBN 978-3-417-02035-9






Die vollständige Backlist
finden Sie im Händlerportal:
haendlerportal.scm-verlagsgruppe.de






Der zweite Band der »Feiert Jesus!« Chorausgabe enthält wieder 30 »Feiert Jesus!«-Lieder in vierstimmigen Chorsätzen. Das Notenheft bietet Kirchen-, Jugend- oder Gospelchören die Gelegenheit, ausgewählte Lieder der beliebten Reihe in ihren Chören umzusetzen. Geschrieben wurden die einzelnen Chorsätze von erfahrenen Satzschreibern wie Anja Goller, Hans-Joachim Eißler u. a.
Günstige Mengenpreise für Ihre Kunden:
10 Stk. für je 16,20 €
20 Stk. für je 15,30 €
30 Stk. für je 14,50 €
50 Stk. für je 13,60 €
• Ideale Ergänzung zu den »Feiert Jesus!«-Liederbüchern
• 4-stimmige Sätze für Chöre (inkl. Gitarrengriffen)
• QR-Codes: Songs direkt anhören und nachspielen
Lieferbar:




Feiert Jesus! Chor 2
Nr. 396.233, € 17,–
€[A] 17,50/CHF 23,–*
Geheftet, 21 × 29,7 cm, 96 S.
ISBN 978-3-7751-6233-3
Erscheint: Oktober 2024




Nr. 395.530












Nr. 395.987




30 ausgewählte Klaviersätze zu beliebten »Feiert Jesus!«-Liedern. Alle Sätze haben ein kurzes Vorspiel und eignen sich hervorragend zur Begleitung der einzelnen Lieder in Gottesdiensten, Hauskreisen oder Kleingruppen. Da es sich um das gleiche Repertoire wie bei der »Feiert Jesus! 2«-Chorausgabe handelt, stellt dieses Buch eine ideale Ergänzung dar. Mit Klaviersätzen von Samuel Jersak, Hans-Joachim Eißler u. a.

• Erfolgreiches Vorgängerprodukt in einer bekannte Reihe
• Für Klavierspieler zur Liedbegleitung
• QR-Codes: Songs direkt anhören und nachspielen
Lieferbar:



Samuel Jersak (Hrsg.) Feiert Jesus! Piano 2 Nr. 396.232, € 20,–€[A] 20,60/CHF 27,–* Spiralbindung, 21 × 29,7 cm, 80 S. ISBN 978-3-7751-6232-6
Erscheint: Oktober 2024




Lieder für zu Hause oder unterwegs
Dieses praktische Liederbuch enthält mehr als 70 beliebte und aktuelle Gemeinde- und Lobpreislieder für zu Hause oder unterwegs. Die Sammlung eignet sich ebenso für festliche Anlässe wie auch für das gemeinsame Singen im Alltag, z. B. im Hauskreis oder während der eigenen Gebetszeit. Auch für Reisen oder Freizeiten ist das kompakte Liederbuch ideal. Die Liedauswahl erstreckt sich dabei von beliebten Chorälen über Klassiker wie »Anker in der Zeit« bis hin zu neueren Liedern wie »10.000 Gründe« oder »Jesus, meine Ho nung lebt«. Ein echtes »Best-of« deutschsprachiger Gemeinde- und Lobpreislieder!
• Bekannte und beliebte Lieder im kompakten DIN-A5-Format
• Ideal für Kleingruppen und Hauskreise
• QR-Codes: Songs direkt anhören und nachspielen

(Auszug)
Anker in der Zeit
Das glaube ich
Der Einzige
Der Herr segne dich
Der Löwe und das Lamm
Der Sieg gehört dir allein
Du großer Gott
Du meine Seele singe Ewigkeit
Für den König
Größer
Güte von Gott
Guter Vater
Heilig für immer
Höher
Ich weiß, wer ich bin
Jesus, meine Hoffnung lebt
Komm, jetzt ist die Zeit, wir beten an Leuchtturm
Lobe den Herren
Mein Gott ist größer
Mittelpunkt
Mutig komm ich vor den Thron
Ruft zu dem Herrn
Schaffe Raum
Schönster Herr Jesus
So groß ist der Herr
So hoch der Himmerl ist
Unser Vater
Wegebner
Welch ein Freund ist unser Jesus
Wie schön dieser Name ist
Wunderbarer Hirt
Zehntausend Gründe






Günstige Mengenpreise für Ihre Kunden:
5 Stk. für je 12,63 €
15 Stk. für je 12,30 €
30 Stk. für je 11,66 €
50 Stk. für je 11,01 €
100 Stk. für je 10,36 €
250 Stk. für je 9,71 €
10.000 Gründe
Das Liederbuch für Gottesdienste, Hauskreise & Freizeiten
Nr. 396.234, € 12,95
€[A] 13,40/CHF 17,50*
Geheftet, 14,8 × 21 cm, 112 S.
ISBN 978-3-7751-6234-0
Erscheint: Juni 2024


















Das neue WDL-Musical
Ein geniales Musical für Kids und Teens von Alexander Lombardi. Inhaltlich geht es dieses Mal um die Geschichte von Saulus, der eine besondere Begegung mit Gott hat, wodurch sein ganzes Leben verändert wird: Aus einem glühenden religiösen Eiferer für das Gesetz wird ein hingebungsvoller Nachfolger Jesu. Die Begegnung mit Gott lässt ihn begreifen, dass Jesus selbst die Erfüllung des Gesetzes ist. Kindgerecht umgesetzt, mit eingängigen Melodien und unterhaltsamen Szenen – musikalisch eindrucksvoll mit großem Kinderchor! Produziert von Gregor Breier.
• Deutschlandweite Musical-Wochen und Freizeiten
• Bekannter Autor und Musiker
• Für Kinder ab 8 Jahren



arbeitet im Leitungsteam des christlichen Kinder- und Jugendwerks »Wort des Lebens e. V.« am Starnberger See. Er schreibt und produziert Musicals und leitet Freizeiten für Kinder und Jugendliche, womit er jedes Jahr ca. 28.000 Menschen erreicht.
wdl.de/musicalfreizeit-kinder








Lieferbar:









Nr. 097.512, € 15,–* €[A] 15,30*/CHF 22,40* CD
EAN 4010276030645
Erscheint: September 2024







Merkwürdige Dinge passieren in der Jugendherberge am Starnberger See. Sind das Feuer, die Überschwemmung und die Entführung eines Gastes nur Zufall oder steckt Sabotage dahinter? Antonias Familie droht der Verlust ihres Zuhauses – eine Gefahr, die sie und ihre Freunde Emma, Jaron und Franky alarmiert. Und welche Rolle spielt Franz Josef von Beilstein, der behauptet, die Seeburg gehöre ihm? Die vier vom See ermitteln und müssen herausfinden, welches Geheimnis sich in der Geschichte der Reihmanns verbirgt.

• Erfolgreiche Kinderbuchreihe
• Geistliches Thema: bei Gott zu Hause sein
• Auftakt der dritten Staffel





Sandra Binder ist Lektorin und Autorin. Lange Jahre war sie Programmleiterin bei SCM Hänssler. Heute verantwortet sie die Redaktion des Universitätsverlags in Tübingen, wo sie mit ihrem Mann und drei Kindern lebt.
Alexander Lombardi arbeitet im Leitungsteam des christlichen Kinder- und Jugendwerks »Wort des Lebens e. V.« am Starnberger See. Er schreibt und produziert Musicals und leitet Freizeiten für Kinder und Jugendliche, womit er jedes Jahr ca. 28.000 Menschen erreicht.

Im modularen Paket

Plakat A3
»Die 4 vom See: Eine verschollene Erinnerung …« Nr. 950.129.001

Mini-Aufsteller
»Die 4 vom See« – 20er-Set Nr. 950.319.005

»Die 4 vom See« auf S. 100 enthalten
Band 8
Sandra Binder, Alexander Lombardi Eine verschollene Erinnerung und die Sehnsucht nach einem Zuhause Nr. 228.103, € 14,95 €[A] 15,40/CHF 20,20* Gebunden, 13,5 × 21,5 cm, 288 S. ISBN 978-3-417-28103-3 Erscheint: Juli 2024




























































MengeAuswahl Positionen







Eine verschollene Erinnerung und die Sehnsucht nach einem Zuhause (228.103)
Die verborgene Gruft (228.841)
Der silberne Schlüssel (228.873)
Ein rätselhafter Unfall (228.855)
Der Wächter der goldenen Schale (228.874)

Operation Falkenstein und die Angst vor dem Unbekannten (228.934)
Der Schatten der Vergangenheit und das schleichende Gift (228.968)
Der Fund in der Tiefe (228.979)
Mysteriöser Einbruch – Hörspiel (940.761)



Spionage im Umweltlabor – Hörspiel (940.762)
Das Bild des Meisters – Hörspiel (940.763)
Die zweifache Täuschung – Hörspiel (940.764)
Das Schwert des Pharao – Hörspiel (940.765)
Ihre individuelle Auswahl bringt bei einer Mindest-Abnahme-Menge satte Rabatte!
Ihre Auswahl


Mit Ihrer Auswahl erreichen Sie folgende Paketstufe 8 Positionen 5 Positionen
Stückzahl ermitteln
Ihre Menge
Erfüllen Sie die Mindest-Abnahme-Menge 25 Stück 15 Stück
Ihr erreichter Rabatt auf die Bestellung 48%46%
GroßKlein

Wenn Sie das Verhältnis von Positionen und Stück erreichen –mehr geht natürlich immer –, erhalten Sie satte Rabatte!

Modulare Pakete erhalten Sie nur über Ihren Vertreter oder bei telefonischer Bestellung über unsere Auftragsbearbeitung.
Volles RR für 18 Monate, Auslieferung: sobald die Titel erscheinen.













Zentrales Thema: Vertrauen und Freundschaft

Die verborgene Gruft und das Ende aller Tränen Nr. 228.841





Zentrales Thema: Umgang mit Andersartigkeit








Zentrales Thema: Ehrlichkeit/ Wahrheit


Ein rätselhafter Unfall und die Suche nach Respekt Nr. 228.855








Zentrales Thema: Schuld und Vergebung Operation Falkenstein und die Angst vor dem Unbekannten Nr. 228.934









Zentrales Thema: Hoffnung über den Tod hinaus














Der silberne Schlüssel und das Geheimnis der Wahrheit Nr. 228.873
Zentrales Thema: Nächstenliebe









Der Wächter der goldenen Schale Nr. 228.874

Zentrales Thema: Lüge, Vertrauen und Wahrheit
Der Schatten der Vergangenheit und das schleichende Gift Nr. 228.968


Der Fund in der Tiefe Nr. 228.979


















Die einen tun es absichtlich, die anderen aus Versehen –doch irgendwann testet jedes Kleinkind die Zuverlässigkeit der Erdanziehungskraft. Wieder und immer wieder. Wie gut, wenn Eltern auf Autofahrten oder beim Spazierengehen mit Buggy nicht ständig das Buch vom Boden aufheben müssen, weil es gut befestigt ist!

• Fünf Bibelgeschichten für die Kleinsten
• Mit Clip einfach am Buggy oder Kindersitz befestigen
• Klein und handlich
Enthaltene Geschichten: Die Schöpfung; Die Arche Noah; Jesus wird geboren; Der gute Hirte; Jesus und die Kinder.


Bethan James, Tanja Husmann (Illustr.)
Die Buggy-Bibel
Nr. 228.097, € 9,95
€[A] 10,30/CHF 13,40* Pappbilderbuch, 9 × 9 cm, 10 S. 4-farbige Innengestaltung
ISBN 978-3-417-28097-5
Erscheint: Juni 2024

Gott sagt zu Noah: „Bau ein großes Schiff!“ In dem Schiff sind alle sicher: Noah, seine Familie und die Tiere.




In einem Stall wird Jesus geboren. Er ist Gottes Sohn. Er liegt in einer Futterkrippe, weil es woanders keinen Platz gibt.
»Ich habe einen besonderen Freund. Er heißt Jesus. In seine Hand schlage ich gerne ein. –Mach mit!« Wer in die passend zum Text illustrierte Hand einschlägt, ist gleich mittendrin im Geschehen. Es werden Seiten geschaukelt, beim Laubfegen geholfen und Kinder getröstet. Ein Immer-wieder-vorleseBuch und eine tolle Grundlage für Gespräche!























Schlag ein!
• Erklärt kindgerecht, was es bedeutet, Jesus als Freund zu haben
• Mitmachbücher sind beliebt und machen Spaß
Lieferbar:








Heike Link, Morena Forza (Illustr.) Jesus ist immer da Schüttel, schaukel, puste mit!
Nr. 228.088, € 14,95
€[A] 15,40/CHF 20,20* Pappbilderbuch, 22 × 22 cm, 22 S. 4-farbige Innengestaltung
ISBN 978-3-417-28088-3
Erscheint: Juli 2024






• Relaunch der beliebten Magnet-Spiel-Bücher
• Einzigartige Reihe im christlichen Buchmarkt
Vier der schönsten Tiergeschichten aus der Bibel laden zum Entdecken ein: die Schöpfung, Noah und die Arche, Elia und die Raben, Jona. Wunderschöne, detailreiche Illustrationen verzaubern Eltern wie Kinder. Die Seitengestaltung lässt viel Raum für die beiliegenden Magnete. Zusätzlich bieten kleine Suchaufgaben eine Vielfalt an Spielmöglichkeiten.
• Magnetische Buchseiten und 20 passende Magnetfiguren







Passend: Meine Magnet-Bibel-Geschichte von Weihnachten auf S. 120
Anita Schalk, Tanja Husmann (Illustr.)
Meine Magnet-Bibel-Geschichten von Tieren
Ein Spielbuch mit 20 Magneten
Nr. 228.101, € 18,–
€[A] 18,60/CHF 24,30*
Gebunden, 25 × 20 cm, 12 S.
ISBN 978-3-417-28101-9
Erscheint: September 2024

EliaunddieRabenEliawareinMann,derGottliebhatte. EinmalmussteEliasichvoreinembösen Königverstecken.GottzeigteEliaeinen geheimenOrtaneinemBach.Dort bliebElia.AusdemBachkonnte ertrinken.JedenMorgenundjedenAbend schickteGotteinpaarRabenzuElia.Siebrachten ihmBrotundFleischmit.SohatteEliaimmer genugzuessenundderböseKönigkonnteihn nichtfinden.



















Was ist Liebe und was kann sie alles?
Niedliche Reime zeigen schon den Kleinsten, dass Liebe geduldig und freundlich ist und niemals versagt. Das Buch holt die Aussagen aus 1. Korinther 13 in die Erfahrungswelt der Kinder. Die liebevoll gereimten Verse mit den niedlichen Tierillustrationen sind ideal zum Vorlesen und bestärken kleine Kinder darin, dass sie bedingungslos geliebt sind.





• Vermittelt Kindern Geborgenheit und stärkt das Selbstwertgefühl
• Bietet eine Grundlage für erste Gespräche über Gottes Liebe


Liebe vertraut
1.Korinther13,7





Was ist Liebe?Weißt du es? Ichwerd’dirdieWahrheitsagen, und dich nicht beschwindeln, an gutenwieanschlechtenTagen. Was kann Liebe?Weißt du es?





Blick ins Buch
Glenys Nellist, Cee Biscoe (Illustr.)
Was ist Liebe? Weißt du es?
Nr. 228.091, € 12,95
€[A] 13,40/CHF 17,50*
Gebunden, 14,8 × 21 cm, 32 S. ISBN 978-3-417-28091-3
Erscheint: Juni 2024



„Aber


schlägtsievor.„WasistdenneinKobel?“fragtWandaneugierig. „DasistmeinNest.WirEichhörnchennennenesKobel.Ichhabeesmir obenindiesemBaumdaausZweigengebaut.“EddazeigtaufeinenBaum gegenübervonWandasHöhle.InderBaumkronekannWandaeinkugeli gesNesterkennen. „Da oben wohnst du?“, fragt sie erstaunt. „Ist das nicht viel zu hoch? Undistdasnichtgefährlich?“„Nun,wirEichhörnchenlebennuneinmalindenBäumen.Wirkönnen gutklettern.UndunserSchwanzhilftuns,dasGleichgewichtzubehalten“, erklärtEdda.„UndobenimBaumfühlenwirunssichereralsuntenaufder Erde.“„Aberdubistdochjetzthierunten“,wirftWandaein. „Jaklar“,stimmtEddazu.„Dasliegtdaran,dassmeineEichelnhierver graben sind.“ Sie gräbt in derErde. „Schau mal, hierist eine“, ruft sie begeistert. „Und hier noch eine! Möchtest du sie essen?“ Edda hält Wanda eineEichelhin. „Ohja,sehrgern!“WandagreiftzuundbeißtindieEichel.Istdaslecker! SiehatschonlangekeineEichelmehrgegessen. „Also,wasistnun?“,meintEdda,nachdemauchsieeineEichelgeges senhat.„KommstdumitinmeinenKobel?Dakönnenwirunsgegenseitig wärmen.“Wanda überlegt. Es ist ja wirklich sehr kalt. Aber der Baum ist sehr hoch.UndwaswerdenihreElterndenken,wennsiezurückkommenund Wandanichtdaist?Währendsienochüberlegt,hörtsieStimmen.
„Oh, ich glaube, meine Familie kommt zurück!“, sagt Wanda

Sie ist ein bisschen enttäuscht. Jetzt kann sie sich ja mit ihrenGeschwisternindieHöhlekuscheln.AbereigentlichwäresieschongernmitEddaindenKobelgeklettert. Edda merkt, dass Wanda ein bisschen traurig ist. „Das istdochprima“,meintdasEichhörnchen.„Dannkannstdu siejadirektfragen,obdumitzumirkommenkannst.“ WandasAugenstrahlen.SoeineguteIdee!SieläuftihrerFamilieentgegenundfragihreMutter,obsiemitinEd-
ih rerFamilieentgegenundfragihreMutter,obsiemitinEd dasKobeldarf. nebenein noch. ab hinauf
Schließlichwohnen sie schon eine ganzeWeile nebeneinander–oderbesserübereinander–imWald. „Na dann los!“, ruft Edda. Doch Wanda zögert immer „Ich weiß nicht, ob ich den Baum hochklettern kann“, meintsieschließlich.„Dasistjaschonsehrhoch…“ „Keine Angst!“, meint Edda. „Ich klettere hinter dir. Dann kann ich dich auffangen, wenn du abrutschst. Oder ein bisschen schieben“, fügt sie grinsendhinzu. Jetzt ist Wandas Ehrgeiz geweckt. „Undobichdasschaffe!“,ruftsielaut. Sie beginnt, den Baum hinaufzuklettern. Die ersten Meter MogegenübervonWandasHöhle.InderBaumkronekannWandaeinkugelibe


Wandas Mama erlaubt es ihr. Sie kennt Edda gut.







Der Wald … genau der richtige Ort, um zur Ruhe zu kommen.
Einfühlsam erzählt Bettina Wendland in 25 Geschichten von Übermut, Lebensfreude, Kompromissen, Versöhnung und anderen Themen, die jedes Kind kennt. Da ist Flecki Fledermaus, die nicht winterschlafen will. Waldkauz Waldemars Ruhe wird vom Klopfen des Spechts gestört und Wanda, der Maus, ist es zu kalt zum Schlafen. Und so finden wir uns kurz vor dem Schlafengehen mitten in den kleinen Alltagsabenteuern der Waldtiere wieder. Sie bieten die Grundlage für einen ruhigen Tagesabschluss und die Möglichkeit, mit dem Kind über den vergangenen Tag zu sprechen. Gedanken an einen liebenden Gott begleiten das Kind in den Schlaf.
• 28 farbige Illustrationen laden zum Träumen ein
• Vorformulierte Fragen helfen, ins Gespräch zu kommen

• Mit thematisch passenden Gebeten fürs Abendritual





hat Lesen und Schreiben schon immer geliebt. Nach ihrem Studium der Literaturwissenschaft wurde sie Redakteurin und arbeitet heute bei der Zeitschrift Family. Mit ihrem Mann und ihren beiden Kindern lebt sie in Bochum. Ihre Leidenschaft für Bücher und für Familie vereint sie in ihren Buchprojekten.
Plakat A3











Volles
Bettina Wendland, Charlotte Pepper (Illustr.) Gute Nacht, Fuchs und Hase! Einschlafgeschichten aus dem Wald. Mit Gebeten
Nr. 228.089, € 14,95
€[A] 15,40/CHF 20,20* Gebunden, 17 × 24 cm, 128 S. ISBN 978-3-417-28089-0
Erscheint: August 2024



Immer mehr Grundschüler können immer schlechter lesen. Gerade diejenigen, denen das Lesen noch schwerfällt, brauchen niederschwellige Lektüre: Lesen soll sich gut anfühlen, die Geschichten müssen Spaß versprechen, Bilder fördern die Konzentration und einfache Sprache das Verständnis. All das bieten die SchlunzComics! Dieser Doppelband enthält alle Comics aus »Der Schlunz – Locker bleiben!« und »Der Schlunz – Streiche zu verkaufen«.
• Vergriffene Schlunz-Comics hiermit wieder lieferbar
• Lustige Geschichten mit christlichen Gedankenanstößen
• Super zur Leseförderung geeignet
Harry Voß, TOBIAS (Illustr.)
Der Schlunz – Action, Wumms und Schleuderwippe
Nr. 228.104, € 12,99
€[A] 13,40/CHF 17,50*
Paperback, 21 × 29,7 cm, 96 S. 4-farbige Innengestaltung
ISBN 978-3-417-28104-0
Erscheint: Juni 2024
Lieferbar:





















In MORE kids – Die Sportbibel für Kinder berichten 24 Sportlerinnen und Sportler, was sie mit Jesus erlebt haben und wie er ihnen in schwierigen Situationen hilft. Mit dabei sind bekannte Profis und andere, die ihren Sport aus Spaß betreiben. Neben den Berichten und Geschichten sind die wichtigsten neutestamentlichen Texte der Bibel und das Lukas-Evangelium abgedruckt, mit lesefreundlich und kindgerecht gestalteten Seiten der bekannten und erfolgreichen »Die Bibel – Übersetzung für Kinder«.
Mit bekannten Fußballern wie Felix Nmecha (Borussia Dortmund, Deutsche Nationalmannschaft) und Felix Uduokhai (FC Augsburg, Deutsche U21 Nationalmannschaft) oder Leichtathletin Yemisi Ogunleye (Deutsche Vizemeisterin und Vizeweltmeisterin im Kugelstoßen)




• Passend zur EM und Olympia: Zusatzseiten rund um den Sport
• Nach dem Konzept der erfolgreichen »Einsteigerbibel«: mit vielen Illustrationen und Erklärungen


Lieferbar:












ist mein Freund
schrieb mit 17 Jahren meinen ersten Profivertrag bei Manchester City. Mit zwanzig verließ ich den Verein, weil ich es nicht geschafft hatte, in der ersten Mannschaft zu spielen. Ich unterschrieb einen Vertrag beim VfL Wolfsburg, wo es für mich besser lief und ich in der 1. Bundesliga spielen konnte. Es gab in meiner Fußballkarriere aber auch Rückschläge, insbesondere dann, wenn ich stark gewachsen war. Der erste kam, als ich ca. fünfzehn Jahre alt war. Ich wuchs so schnell, dass ich mich nicht genauso schnell an meinen Körper gewöhnen konnte. Es gab Zeiten, in denen ich zwar ein guter Spieler war, aber es auf dem Platz nicht zeigen konnte. Auch nachdem ich ausgewachsen war, gab es noch Probleme. Eine Verletzung an einer Sehne im Knie setzte mich einmal neun Monate lang außer Gefecht.













Über 200 Sticker mit Sportmotiven
Beispielhafte Innenseiten (vorläufi g)
Verteilausgabe im 5erPack
MORE kids
Die Bibel – Übersetzung für Kinder, Texte aus dem Neuen Testament Verteilausgabe, 5er-Pack Nr. 228.105, ca. € 29,–€[A] ca. 29,90/CHF ca. 39,20* Paperback, 14,8 × 21 cm, 240 S. ISBN 978-3-417-28105-7 Erscheint: Juni 2024




Manfred hat einen Traum: Er will Tiermedizin studieren und vom Hof seines alkoholkranken Vaters flüchten. Schweren Herzens lässt er seinen Bruder Samuel und seine große Liebe Fanny zurück. Doch der Erste Weltkrieg macht seine Studienpläne zunichte. In den Schützengräben an der Westfront zweifelt Manfred am Krieg und verabscheut die vielen Opfer, die er mit sich bringt. Als alles verloren scheint, strahlt plötzlich ein Licht des Friedens auf und Feinde begegnen sich an Heiligabend. Es beweist: Der Blick auf das Kind in der Krippe ändert alles. Ein Roman über Glaube und Zweifel, Ho nung und Feindschaft – und die Frage, wie viel Mut es braucht, um für ein wenig Frieden zu kämpfen.
• Nach einer wahren Geschichte, die sich im Jahr 1914 an der Westfront abspielte

• Ermutigt, an Versöhnung zu glauben, wo wir es am wenigsten erwarten


• Ein berührender Roman über den »Weihnachtsfrieden« im Ersten Weltkrieg






arbeitet seit vielen Jahren für Schweizer Medien. Für ihre journalistischen Texte sowie Kurzgeschichten wurde sie bereits mehrfach gewürdigt. Ihr Wunsch und Ziel ist es, außergewöhnliche und spannende Geschichten zu erzählen und den Leser damit zu fesseln. Sie ist verheiratet und hat drei Söhne.
Sammelleseprobe
»Romane Herbst 2024« – 25er-Set
Nr. 950.126.002











Muhl Ein Lied für den Feind Nr. 396.193, € 23,–€[A] 23,70/CHF 31,10* Paperback, 13,5 × 21,5 cm, 304 S. ISBN 978-3-7751-6193-0 Erscheint: September 2024



Was bedeutet der Adventskranz?
Hamburg 1835: Als die Kinder des »Rauhen Hauses« eines Abends in den Speisesaal kommen, staunen sie nicht schlecht: Von der Decke hängt ein Wagenrad mit vier großen weißen und 19 kleinen roten Kerzen. Jeden Tag entzündet Heimleiter Wichern nun eine weitere Kerze, die an Jesus, das Licht der Welt, erinnert und den Kindern zeigt, wie nah Weihnachten gekommen ist. Mit dem beigelegten Wagenrad aus festem Papier können die kleinen Leserinnen und Leser einen solchen Wichernkranz ganz einfach nachbauen, auf dem für jeden Tag ab dem ersten Advent eine Papierkerze Platz findet. Material und Bastelanleitung sind im Buch enthalten.
• Weihnachtsbrauch anschaulich erklärt
• Verdeutlicht, worum es an Weihnachten geht
• Zum Heraustrennen: beigelegtes Wagenrad-Poster für Advents-Ritual und 4 Seiten zum Ausschneiden der Kerzen



(Jg. 1972) arbeitet als Grundschullehrerin und liebt es, Kindern Werte und Lerninhalte so zu vermitteln, dass sie hängen bleiben. Neben zahlreichen Verö entlichungen von Liedern, Reimen, Fingerspielen, Hör- und Klanggeschichten, Bühnen- und Gottesdienstprogrammen ist Geschichten zu Papier zu bringen ihre neue Leidenschaft.
www.sabinewiediger.de











Papierkerzen für jeden Tag im Advent



ls Greta am nächsten Morgen zum Speisesaal eilt, hört sie schon von Weitem laute Stimmen. Seltsam, so etwas erlaubt Herr Wichern nie! Doch da steht er – inmitten einer Menge aufgeregter Kinder! Greta hört Wortfetzen wie: „Dauert es noch lange?“ „Wann endlich?“ Neugierig stupst sie ihre Freundin Karoline an: „Worum geht es denn?“ „Um Weihnachten“, flüstert die mit leuchtenden Augen zurück. „Ruhe, Ruhe!“, tönt die tiefe Bassstimme von Herrn Wichern durch den Raum. Sofort ist es mucksmäuschenstill.
Greta spitzt die Ohren. „Es sind nur noch wenige Wochen bis Weihnachten.“ Herr Wichern hält inne. Sein Blick wandert zum Fenster, weil ihn das knirschende Geräusch der einfahrenden Postkutsche ablenkt. Ungeduldig zupft der kleine Peter an Herrn Wicherns Jacke: „Wievielmal schlafen?“, will er wissen. Plötzlich huscht ein verschmitztes Lächeln über Herrn Wicherns Gesicht. „Mir kommt gerade eine Idee.“ Voller Tatendrang klatscht er in die Hände: „Wartet es ab. Und jetzt rasch an die Plätze! Frühstückszeit!“

Im modularen Paket »Weihnachten« auf S. 126 enthalten
Sabine Wiediger, Nadine Hasselwander (Illustr.) Greta wartet auf Weihnachten –Wie der Adventskranz erfunden wurde Mit Bastelkerzen Nr. 228.099, € 17,–€[A] 17,50/CHF 23,–* Gebunden, 24 × 24 cm, 32 S. ISBN 978-3-417-28099-9
Erscheint: September 2024





Handlich, aber doch mit großformatigen Bildern:
Dieses Buch ist größer, als es scheint!
Große Bilder für kleine Kinder! Mit seinem handlichen Format ist dieses Buch genau richtig für Kinderhände. Spielend leicht lassen sich die großformatigen Bilder aufklappen und sorgen für freudiges Staunen im Kinderzimmer. Bäuchlings auf dem Teppich liegend erkunden die Kleinen, was es mit Maria und Josef, den Hirten, den Weisen und der Krippe im Stall auf sich hat. Für eine Advents- und Weihnachtszeit, in der die Geburt Jesu im Mittelpunkt steht! Mit Bibelstellenangabe zum Nachlesen der Weihnachtsgeschichte.
• Genialer Ausklapp-Mechanismus
• Fünf große Szenen: 35 × 35 cm
• Mit Suchaufgaben und süßen Details










Vorteilsangebot »Das große Wunder im kleinen Stall«
Bestell-Nr. Buch 220.000.404
Groß*Klein
10× 5× Das große Wunder (…) Stall (228.090) 48%46%Rabatt
83,20 €D43,20 €DNetto-Einkaufswert
160,– €D 80,– €DGesamt-Brutto-Verkaufswert
Volles RR für 18 Monate, Auslieferung: September * Bei der Bestellung von zwei kleinen Vorteilsangeboten erhalten Sie 48 % Rabatt.
Weihnachten
KINDER AB 3 JAHREN
Erzählt folgende Stationen:
Ein Engel besucht Maria
Maria und Josef reisen nach Betlehem
Jesus wird geboren
Gute Nachricht für die Hirten
Ein Stern zeigt den Weg


Im modularen Paket »Weihnachten« auf S. 126 enthalten
Jael-Deborah Jaensch, Francesca Pesci (Illustr.)
Das große Wunder im kleinen Stall Die Weihnachtsgeschichte zum Auseinanderfalten
Nr. 228.090, € 16,–€[A] 16,50/CHF 21,60* Gebunden, 20 × 20 cm, 5 S. ISBN 978-3-417-28090-6 Erscheint: September 2024


























Hier lässt sich die Weihnachtsgeschichte kreativ entdecken! Mit den 20 passenden Spielfiguren können die Szenen immer wieder neu gestaltet werden: das Gespräch des Engels mit Maria, die Geburt Jesu im Stall, das Erlebnis der Hirten und der Besuch der Weisen. Kleine Suchaufgaben runden das Konzept ab.


• Magnetfiguren haften auf den Buchseiten
• Hochwertiges und langlebiges Produkt
• Liebevoll illustriert von Tanja Husmann







KINDER AB 5 JAHREN









Passend: Meine Magnet-Bibel-Geschichte von Tieren auf S. 104


»Diese Magnetbücher sind echt super! Eine schöne Geschenkidee für einen Kindergeburtstag oder als Beschäftigung für eine längere Autofahrt. Die 20 unterschiedlichen Magnete liegen gut in der Hand. Sie haften beim Umblättern, sind leicht und doch dick genug, damit sie nicht geknickt werden können.«
Elke Pfesdorf, Autorin und Erzieherin
Im modularen Paket »Weihnachten« auf S. 126 enthalten
Anita Schalk, Tanja Husmann (Illustr.)
Meine Magnet-Bibel-Geschichte von Weihnachten
Ein Spielbuch mit 20 Magneten Nr. 228.100, € 18,–€[A] 18,60/CHF 24,30* Gebunden, 25 × 20 cm, 12 S. ISBN 978-3-417-28100-2 Erscheint: September 2024

















In der Advents- und Weihnachtszeit gibt es viele Gelegenheiten, um Geschichten zu hören, zu erzählen oder sie selber zu lesen: im Familienkreis, an verregneten Winterabenden, bei Weihnachtsfeiern in der Gemeinde, mit Freunden oder Nachbarn. Diese liebevoll gestaltete Sammlung enthält eine reiche Auswahl an bekannten und unbekannten Weihnachtsgeschichten, -texten und -gedichten. Die Geschichten sind inhaltlich sortiert und mit Lesezeit versehen. So findet man schnell die passenden Texte zum Schmökern am Kamin oder zum Vorlesen und kann sich mit hineinnehmen lassen in eine wundervolle Weihnachtszeit und in die Botschaft vom Retter der Welt.

und unbekannte Geschichten mit christlicher Botschaft
mit Angabe der Lesezeit























Im modularen Paket »Weihnachten« auf S. 126 enthalten
Annegret Prause (Hrsg.) Zeit der Lichter und Geschichten Weihnachtsgeschichten zum Lesen und Vorlesen Nr. 629.923, € 18,–€[A] 18,60/CHF 24,30* Gebunden, Goldprägung, 4-farbige Innengestaltung, 17 × 23,5 cm, 176 S. ISBN 978-3-7893-9923-7
Erscheint: September 2024






• Adventskalender zum Aufstellen
• Mit 24 Gedanken zum Innehalten
• Aus den Seiten werden Postkarten
Im modularen Paket »Weihnachten« auf S. 126 enthalten
Stennie Friedvoll
24 Wege, um im Advent zur Ruhe zu kommen
Nr. 629.920, € 12,95
€[A] 13,40/CHF 17,50* 11,5 × 17 cm, 24 S. Aufstellbuch
ISBN 978-3-7893-9920-6
Erscheint: September 2024

Sich im Advent jeden Tag an Gottes Gegenwart erinnern lassen und trotz Weihnachtstrubel zur Ruhe finden. Stennie hat 24 Gedanken und Ermutigungen gestaltet, die zum Innehalten einladen. Und das Beste: Aus den Blättern des Adventskalenders können später Weihnachtskarten werden.

























Stennie heißt eigentlich Stefanie Krel. Sie lebt mit Mann und Kindern in Bad Driburg, NRW. Für ihr Label Stennie Studio entwirft sie schöne Produkte, die helfen sollen, im Alltag noch näher an Jesu Herz zu kommen.
Nicht nur der Barbarazweig, auch Worte können in der Adventszeit blühen. 24 solcher Worte hat Jeannette Mokosch mit der Kalligrafie-Feder zu Papier gebracht. Auf liebevoll gestalteten Seiten begleiten sie in diesem Aufstellbuch durch den Advent. Anschließend können sie ganz einfach in Weihnachtskarten verwandelt werden und weiter Freude bringen.
















• Kalligrafie von Jeannette Mokosch
• Dekorativer und ermutigender Adventskalender
• Aus den Blättern werden Weihnachtskarten

Jeannette Mokosch ist Kalligrafiekünstlerin, Grafikerin und Autorin. Mit ihrer Familie lebt sie in der Lüneburger Heide.
Im modularen Paket »Weihnachten« auf S. 126 enthalten
Jeannette Mokosch Blühende Worte – Adventskalender Nr. 629.921, € 12,95
€[A] 13,40/CHF 17,50* 11,5 × 17 cm, 24 S. Aufstellbuch
ISBN 978-3-7893-9921-3
Erscheint: September 2024

MengeAuswahl Positionen



Greta wartet auf Weihnachten – Wie der Adventskranz erfunden wurde
Meine Magnet-Bibel-Geschichte von Weihnachten
Zeit der Lichter und Geschichten (629.923)
Friedvoll – Adventskalender (629.920)
Blühende Worte – Adventskalender
Freut euch, es ist Weihnachten! (821.086)
Der Herrnhuter Stern (817.137)
Himmlische Weihnachtsgrüße – Postkartenset
Jesus hat Geburtstag (940.684)
Zwei kleine Mäuse auf der Suche nach dem großen König
Deine Spuren im Schnee (817.898)
Weihnachtsfreude erfülle dein Herz
Weihnachtsgrüße – Postkartenbox
Die Weihnachtsgeschichte – Mein Vorlese-Wimmelbuch
Auf der Suche nach der Weihnachtsfreude
Das Wichtigste an Weihnachten (228.971)
Weihnachtswunder (940.053)
Feiert Jesus! Gloria (097.462)
Das größte Geschenk (940.680)

Dieses Paket finden Sie auch in der Gerth-MedienVorschau auf S. 106/107

Ihre individuelle Auswahl bringt bei einer Mindest-Abnahme-Menge satte Rabatte!




Stückzahl ermitteln

Ihre Auswahl Mit Ihrer Auswahl erreichen Sie folgende Paketstufe 17 Positionen 14 Positionen
Ihre Menge Erfüllen Sie die Mindest-Abnahme-Menge 40 Stück 25 Stück



Ihr erreichter Rabatt auf die Bestellung 48%46% GroßKlein
Modulare Pakete erhalten Sie nur über Ihren Vertreter oder bei telefonischer Bestellung über unsere Auftragsbearbeitung.
Volles RR für 18 Monate, Auslieferung: sobald die Titel erscheinen

Wenn Sie das Verhältnis von Positionen und Stück erreichen –mehr geht natürlich immer –, erhalten Sie satte Rabatte!

















Geschichten 629.923














Himmlische Weihnachtsgrüße –
Postkartenset 558.408.700












Greta wartet auf Weihnachten –Wie der Adventskranz erfunden Meine Magnet-Bibel-Geschichte von Weihnachten 228.100




















Friedvoll –Adventskalender 629.920








Weihnachtsfreude erfülle dein Herz. 623.518



Weihnachtswunder 940.053


Weihnachtsgrüße –Postkartenbox 558.408.300



Blühende Worte –Adventskalender 629.921


Jesus hat Geburtstag 940.684








Freut euch, es ist Weihnachten! 821.086









Zwei kleine Mäuse auf der Suche nach dem großen König 228.858



Der Herrnhuter Stern 817.137


Deine Spuren im Schnee 817.898



Auf der Suche nach der Weihnachtsfreude 817.986 wurde 228.099
Die Weihnachtsgeschichte –Mein Vorlese-Wimmelbuch 228.922

Feiert Jesus! Gloria 097.462












Das Wichtigste an Weihnachten 228.971


Das größte Geschenk 940.680




»Gott kann Großartiges durch uns tun, wenn wir ihn nur in uns wirken lassen.« In kurzen, erfrischenden Texten macht Maria Prean Mut, ein Leben mit Gott zu wagen, in dem er durch uns wirken kann. Sie erinnert uns an unsere Identität in Christus und daran, dass Gottes Möglichkeiten so viel größer sind als unsere. Die wunderschön gestalteten Seiten des Bildbands lassen die Worte und Gedanken noch lange nachklingen. Ein Buch voller Zuspruch und Ermutigung, das man immer wieder gern zur Hand nimmt und ein wunderbares Geschenk.
• Ermutigende Texte, Gedanken und Bibelverse, die mitten in den Alltag sprechen
• Wunderschön gestaltet, einfach aufgeschlagen liegen lassen
• Ein Geschenk für alle, die etwas Zuspruch, Mut und Rückenwind brauchen


(Jg. 1939) ist Missionarin in Uganda, wo sie sich mit ihrem Verein »Vision für Afrika« für über 5.000 Kinder einsetzt. Sie ist eine beliebte Rednerin bei christlichen Seminaren und Workshops und die erfolgreiche Autorin mehrerer christlicher Bücher.












Maria Prean-Bruni Träume den Traum, den Gott für dich hat Ermutigungen Nr. 629.922, € 16,–€[A] 16,50/CHF 21,60* Gebunden, 21 × 21 cm, 96 S. ISBN 978-3-7893-9922-0 Erscheint: September 2024












40 wunderschön gestaltete Doppelkärtchen mit ermutigenden Gedanken von Maria Prean, Bibelversen und Platz für eine persönliche Botschaft.
Maria Prean-Bruni Loslassen. Gott lassen. 40 Wunschkärtchen Nr. 623.532, € 12,95* €[A] 13,30*/CHF 19,30* 6,5 × 6,5 cm, 40 Doppelkärtchen Erscheint: September 2024

An gute Gespräche erinnert man sich lange zurück. Sie sorgen dafür, dass man sich besser kennenlernt, zusammenwächst, gemeinsam lacht und neue Seiten an sich und anderen entdeckt. Solche guten Gespräche müssen nicht rein zufällig entstehen. Bei der Fragebox herzlich.ehrlich ist der Name Programm. 120 Fragekarten sorgen auf spielerische Weise für Gesprächsthemen. Einfach eine Karte ziehen und überraschen lassen, wohin die Gespräche führen. Perfekt für Freunde, kleine Gruppen, Hauskreise und alle, die sich besser kennenlernen wollen.







• In hochwertiger und praktischer Box
• je 120 Fragekarten für gute Gespräche

• Große Social-Media-Reichweite: Instagram @herzstaerkend

ANZEIGEN
Family Hauskreismagazin teensmag
POSTKARTE
»herzstärkend« – 25er-Set Nr. 950.135.001

































• Für Freunde, kleine Gruppen, Hauskreise und alle, die sich besser kennenlernen wollen
Mit 4 Fragekategorien:
ehrlich ich (Persönlichkeit) tiefes wir (Fragen für die Gruppe) weiter glauben (Glaube & Spiritualität) leicht & los (Challenges)






Herzlich.ehrlich herzstärkend
Echte Verbundenheit
120 Fragen für gute Freunde
Nr. 623.534, € 17,–*
€[A] 17,40*/CHF 25,30*
10,6 × 9,5 × 10,5 cm, 120 Kärtchen (9 × 9 cm) in stabiler Box
Erscheint: September 2024


• 120 Fragekarten für Paare
• Geschenkidee zur Hochzeit, Valentinstag, Jahrestagen oder einfach so
Mit 4 Fragekategorien:
ehrlich ich (Persönlichkeit) tiefes wir (Beziehung) weiter glauben (Glaube & Spiritualität) nackte wahrheit (Sex)


Herzlich.ehrlich herzstärkend
Tiefe Beziehungen
120 Fragen für Paare
Nr. 623.535, € 17,–*
€[A] 17,40*/CHF 25,30*
10,6 × 9,5 × 10,5 cm, 120 Kärtchen (9 × 9 cm) in stabiler Box
Erscheint: September 2024
Der Begleiter durchs Jahr für alle, die keine Vielschreiber sind, aber trotzdem mehr mitnehmen und erinnern möchten. Das Journal teil sich in 3 Abschnitte: den Monatsteil, der die besonderen Erinnerungen einfängt. Den Jahresrückblick, der die großen Linien nachzeichnet, und den Vorausblick, der herausfindet, was im nächsten Jahr dran sein könnte. Erklärende Texte, kurzweilige Fragen und »Aufgaben« (zum Ankreuzen, mit Skalen, Platz zum Einkleben, Raum für kürzere Texte) sorgen für Abwechslung und machen das Ausfüllen entspannt. So nimmt man wertvolle Erinnerungen und Erkenntnisse mit, ohne seitenweise schreiben zu müssen.
• Erinnerungen, Erkenntnisse und besondere Momente aus einem Jahr festhalten
• Mit abwechslungsreichen Fragen und Aufgaben
• Funktioniert auch für Wenigschreiber und ohne Schreibstress

ist Kommunikationswissenschaftlerin und fasziniert von Worten und allem, was man damit machen kann. Sie arbeitet als Lektorin, schreibt nebenher Bücher und für Zeitschriften.


















Annegret Prause Leben. Glauben. Wachsen. Jahres-Journal für Erinnerungen, Eindrücke und Erkenntnisse Nr. 629.924, € 14,95 €[A] 15,40/CHF 20,20* Gebunden, 14,8 × 21 cm, 144 S. 4-farbige Innengestaltung, Lesebändchen
ISBN 978-3-7893-9924-4
Erscheint: September 2024







Den Alltag organisieren und gleichzeitig daran erinnert werden, dass man nicht alles alleine scha en muss, weil Jesus mittendrin ist? Stennie verbindet in ihrem Wochenplaner beides – und das auf wunderschöne Weise. Er enthält großzügige Doppelseiten für jede Woche mit Platz für Termine, To-dos, Gedanken und Pläne, Monatsübersichten, nützliche Listen, Raum für Notizen u. v. m. Monatliche Impulse, Fragen zum Reflektieren, gestaltete Seiten mit Zitaten und Bibelversen sorgen dafür, dass der Blick immer wieder zu Jesus findet. Der Planer ist undatiert – man kann ihn jederzeit beginnen und ganz den persönlichen Bedürfnissen anpassen.
• Wochenplaner mit Monatsübersichten, nützlichen Listen u. v. m.
• Mit Impulsen, Fragen und Anregungen zum Reflektieren, vielen gestalteten Seiten
• Undatiert: jederzeit beginnen und den persönlichen Bedürfnissen anpassen

heißt eigentlich Stefanie Krel. Sie lebt mit Mann und Kindern in Bad Driburg, NRW. Für ihr Label Stennie Studio entwirft sie schöne Produkte, die helfen sollen, im Alltag noch näher an Jesu Herz zu kommen.
INSTAGRAM: @stennie













ich


TUT ES.


in
Zumeinem33.GeburtstagschenktenmirmeineFreundinneneineKartemit liebevollenWortenundWünschen.InderKartestand,fastwieeinNebensatz,derSpruchaufderlinkenSeite.DieAussagetrafmitteninmeinHerz,denn ichbinMeisterinderOrganisation:IchkriegeeinenVollzeitjob,meinenHaushaltundMuttersein
Gemeinde undpflegeBeziehungen.Ichliebees,zureisenundNeueszusehen,michvon TrendsinspirierenzulassenunddarausganzeigenecooleDingezukreieren. Kurz:IchliebeesdasLebenzuergründen.Abereinshabeichwirklichmeistens Ruheistetwas,wasichmirauchganzlangenichtzugestehenwollte.Vielzu langedachteich,dassichdasüberhauptnichtbrauchte-ichbinjung,effektiv undbelastbar.Aberichwunderemichrückblickendnicht,wiesoichmitEnde 20nurknappeinemBurnoutentkommenbin.Nein,meineFreundinnenhatten mitihremBriefrechtundichbindankbar,fürdieErinnerungdaran,dassselbst dieperfektorganisierteGeschäfitgkeitkeineRuhebringt.Wirkönnenunsdieses biblischePrinzipnichtzuvielvorAugenhalten:Wirdürfen-nein,wirmüssen -zurRuhekommen.

unsereUnsicherheiten,unsereBelastungenunddasganzeLebenaktivinGottesHändelegen.Immerundimmerwieder. ZUR RUHE KOMMEN WER IM SCHUTZ DES HÖCHSTEN LEBT, DER FINDET





Stennie Mein Alltag, Jesus und ich Undatierter Planer mit Ermutigungen und Platz für Reflexion Nr. 629.925, € 20,–€[A] 20,60/CHF 27,–* Flexcover, 17 × 23,5 cm, 208 S. Kunstledereinband, mit Leseband ISBN 978-3-7893-9925-1
Erscheint: Juli 2024









VorschauFJS.114-115

Wunderbar Wir
Nr. 629.912, € 20,–
€[A] 20,60/CHF 27,–*












Geschirrtuchset –Stennie Studio
Nr. 623.524, € 16,–*
€[A] 16,40*/CHF 23,80*

















Lasst Liebe blühen
Nr. 629.917, € 14,95
€[A] 15,40/CHF 20,20*





















Leben in Fülle –40 Wunschkärtchen
Nr. 623.517, € 12,95*




Immer nah 30 Ermutigungen für Dich
Nr. 629.906, € 12,95
€[A] 13,40/CHF 17,50*








€[A] 13,30*/CHF 19,30*



















Notizbuch mit Knopf –Mein Leben in Fülle
Nr. 623.526, € 12,95*
€[A] 13,30*/CHF 19,30*



Kugelschreiber-Set »Immer nah«

Nr. 623.521, € 14,95*


€[A] 15,30*/CHF 22,30*


Notizbuch »Ich bin dir nahe«
Nr. 623.511, € 12,95*
€[A] 13,30*/CHF 19,30*


























Notizbücher



Gebunden, 14,8 × 21 cm, 176 S.
»God’s grace is with you every moment«

Nr. 623.512, € 12,95*
€[A] 13,30*/CHF 19,30*
»God never leaves your side«
»Grow in Grace«
Nr. 623.501, € 12,95*

€[A] 13,30*/CHF 19,30*
100 Tage Grace & Hope Andachts-Journal
Nr. 629.903, € 16,–
€[A] 16,50/CHF 21,60*
Neues Leben. Die Bibel.
Nr. 225.389, € 25,–
€[A] 25,70/CHF 33,80*














Nr. 623.527, € 12,95*
€[A] 13,30*/ CHF 19,30*




















Postkarten-Set
Nr. 623.480, € 14,99*
€[A] 15,30*/CHF 22,30*
Always put your hope in God
Nr. 629.904,€ 12,95
€[A] 13,40/CHF 17,50*
Pray more. Worry less –Tagesplaner Abreißblock
Nr. 623.528, € 9,95*
€[A] 10,20*/CHF 14,80*

50 × Gnade und Ho nung für dich
Nr. 623.450, € 9,95*
€[A] 10,20*/CHF 14,80*

Blessing upon blessing
Kombi-Aufstellbuch
Nr. 629.915, € 14,95
€[A] 15,40/CHF 20,20*


























Besondere Kärtchen voller Gnade und Honung. Das Besondere: Die Kärtchen lassen sich aufstellen. Klappt man sie auf, entdeckt man im Inneren einen ermutigenden Bibelvers und Platz für eine persönliche Botschaft, einen Wunsch oder einfach einen kleinen Gruß. Perfekt zum Weitergeben!


• 40 unterschiedliche Kärtchen
• Im beliebten »Grace & Hope«-Stil
• Als kleine Ermutigung aufstellen oder mit Grußbotschaft weiterschenken
Grace & Hope – 40 Wunschkärtchen
Nr. 623.533, € 12,95*
€[A] 13,30*/CHF 19,30*
6,5 × 6,5 cm, 40 Doppelkärtchen in Geschenkbox
Erscheint: September 2024




Die Tasse aus der beliebten »Grace & Hope«-Reihe mit dem Vers »Be still and know that I am God« macht kleine Pausen zu einer Auszeit. Mit Golddekor.




Tasse »Be still and know« – Golddekor
Nr. 623.537, € 14,95*
Nr. 623.537, € 14,95*
€[A] 15,30*/CHF 22,30*
Erscheint: September 2024

Das Journal für bewusste Zeit mit Gottes Wort. Mit Tipps, Anregungen, Lese-Trackern u. v. m. unterstützt es beim Bibellesen. Gut strukturierte und liebevoll gestaltete Journalseiten lassen Raum, um Erkenntnisse und Gedanken festzuhalten. So wird die Zeit mit der Bibel nicht nur intensiver, ganz nebenbei dokumentiert man die eigene Glaubensreise und behält wichtige Verse und Gedanken in Erinnerung.






• Liebevoll gestaltete Seiten für Bibelnotizen
• Mit praktischen Tipps, Anleitungen, Bibelleseplänen, Lese-Tracker ...
• Die eigene Reise mit Gottes Wort dokumentieren
Lieferbar:




Nr. 629.909
Bibellese-Journal Gott in der Bibel begegnen Nr. 629.919, € 12,95
€[A] 13,40/CHF 17,50* Gebunden, 14,8 × 21 cm, 192 S. 4-farbige Innengestaltung, Lesebändchen
ISBN 978-3-7893-9919-0
Erscheint: August 2024





Seit 25 Jahren begeistert dieser Kalender Frauen. Er hilft ihnen mit einem genialen Konzept dabei, ihren Alltag zu organisieren und zu dokumentieren – er ist Terminplaner und Tagebuch in einem. Die Kalenderseiten lassen viel Raum für Termine, Notizen, Gedanken und Erinnerungen. Mit vielen praktischen Listen, Übersichten und Notizseiten.
• Planer und Tagebuch in einem
• Seit 25 Jahren ein treuer Begleiter für Tausende Frauen
• Mit vielen Fotos, inspirierenden Bibelversen und Zitaten












»Das Kalender-Tagebuch ist mir ein guter Begleiter für meinen beruflichen und privaten Alltag, mit dem ich meine Termine gut im Griff habe. Ich schätze auch, dass immer genügend Platz für Notizen und persönliche Dinge ist. Das Buch begleitet mich fast überallhin.«
»Ich möchte diesen Kalender nicht mehr missen!«
»Ich finde das Kalender-Tagebuch ›Mein Jahr‹ sehr gut und organisiere damit unsere 6-köpfige Familie.«
Bianka Bleier
Mein Jahr 2025
Nr. 624.503.025, € 20,–*
€[A] 20,40*/CHF 29,80*
Gebunden, 15 × 21 cm, 464 S. 4-farbige Innengestaltung, 2 Lesebändchen
ISBN 978-3-7893-4997-3
Erscheint: Juni 2024




Die Bibellesehilfe für alle, die ihre Beziehung zu Gott und ihr Verständnis der Bibel vertiefen wollen. Die beliebten »Lichtstrahlen« begleiten die tägliche Bibellese mit erklärenden und zum Nachdenken anregenden Texten – geschrieben von mehr als 50 verschiedenen Autoren und Autorinnen. Mit Platz zum Festhalten von wichtigen Gedanken zum Bibeltext und mit Einführungen in die biblischen Bücher der Bibellese. Zusätzlich finden sich im vorderen Teil des Buches mehrere Seiten mit inspirierenden und herausfordernden Gedanken zur aktuellen Jahreslosung.
• Mit passend gestaltetem Lesezeichen
• Mit verschiedenen Gebeten für bestimmte Lebenslagen sowie Impulsen zum Thema Gebet
• Begleiter für jedes Jahr neu






»Lichtstrahlen 2025«
Nr. 950.132.001





Deutscher Jugendverband »Entschieden für Christus« (EC) e. V. (Hrsg.)
Lichtstrahlen 2025
Nr. 182.650, € 9,95
€[A] 10,20/CHF 13,40*
Paperback, 12,5 × 19 cm, 256 S. ISBN 978-3-87092-650-2
Erscheint: September 2024



Seit mehr als 75 Jahren ist dieses kleine Heft ein Bestseller. Über jedem Tag steht einer der 365 markanten, geistlichen Aussprüche. Diese lassen sich gut merken und geben einen täglichen, geistlichen Impuls. Bibelversangaben laden zum Weiterlesen ein. Ein inspirierender Begleiter durchs Jahr, der sich dank des günstigen Preises auch sehr gut verschenken lässt.






• Seit mehr als 75 Jahren ein Bestseller!
• Ein kurzer Gedanke für den Start in den Tag
Der Andachtskalender begleitet eine tägliche Bibellese. Mehr als 230 Autoren aus dem Bund Freikirchlicher Pfingstgemeinden, der Gemeinde Gottes, der Schweizerischen Pfingstmission und der Freien Christengemeinden Österreichs haben Andachten in ihrem ganz persönlichen Stil beigetragen. Was alle verbindet: aus Gottes Wort inspirierte und inspirierende Impulse weiterzugeben. Egal, ob jemand die Bibel zum ersten Mal liest oder langjähriger »Bibelforscher« ist: Für jeden ist etwas dabei.
• Wertvolle Impulse für das ganze Jahr
• Herausgegeben vom Bund Freikirchlicher Pfingstgemeinden
• Tägliche Bibellese mit Andacht
Morgengrüße – 79. Folge
Nr. 624.505.025, € 1,95
€[A] 2,10/CHF 2,60*
Geheftet, 10,7 × 14,8 cm, 32 S.
ISBN 978-3-7893-4998-0
Erscheint: Juni 2024
Inspiration durch Gottes Wort 2025
Täglicher Begleiter für 2025
Nr. 624.976.025, € 12,50
€[A] 12,90/CHF 16,90*
Paperback, 13,6 × 21 cm, 400 S.
ISBN 978-3-7893-4999-7
Erscheint: Juni 2024
Der traditionsreiche Kalender mit biblischen Betrachtungen für alle Tage des Jahres. Kurze Geschichten oder vertiefende Betrachtungen helfen, Inhalt und Sinn der Verse besser zu verstehen und in den eigenen Alltag zu übertragen.

















Wort für heute 2025 –Großdruck-Buchkalender
Nr. 299.992.025, € 19,50
€[A] 20,10/CHF 26,30*
Flexcover, 12,4 × 18 cm, 752 S.
ISBN 978-3-86258-129-0
Erscheint: August 2024
Wort für heute 2025 –Buchkalender
Nr. 299.882.025, € 14,80
€[A] 15,30/CHF 20,–*
Kartoniert, 11 × 15 cm, 752 S.
ISBN 978-3-86258-128-3
Erscheint: August 2024
Wort für heute 2025 –Abreißkalender
Nr. 299.881.025, € 14,80*
€[A] 15,10*/CHF 22,10* 11 × 15 cm, 376 S.
ISBN 978-3-86258-127-6
Erscheint: September 2024
























Martin Gundlach (Hrsg.)
Erzähl mir dein Leben –Leinenausgabe
Ein Fragebuch an Oma und Opa
Nr. 629.819, € 20,–
€[A] 20,60/CHF 27,–*
ISBN 978-3-7893-9819-3








































Wir beide. Für immer. Erinnerungsbuch für alle unsere Ehejahre
Nr. 629.832, € 16,99




€[A] 17,50/CHF 22,90*
ISBN 978-3-7893-9832-2









Martin Gundlach (Hrsg.) Erzähl mir dein Leben

Ein Fragebuch an Oma und Opa
Nr. 629.323, € 20,–
€[A] 20,60/CHF 27,–*
ISBN 978-3-7893-9323-5



Veronika Smoor
Co ee and Jesus
Kleine Auszeiten mit ein bisschen
Ka ee und viel Jesus
Nr. 629.877, € 12,95
€[A] 13,40/CHF 17,50*
ISBN 978-3-7893-9877-3













Maria Prean-Bruni Mit Gottes Flügeln kannst du fliegen Ermutigungen











Nr. 629.446, € 14,99
€[A] 15,50/CHF 20,20*
ISBN 978-3-7893-9446-1

Christina Brudereck Für alles gibt es eine Zeit Rituale für Tag, Jahr und Leben
Nr. 629.813, € 17,–
€[A] 17,50/CHF 23,–*
ISBN 978-3-7893-9813-1
















Prayer Journal
Nr. 629.909, € 12,95
€[A] 13,40/CHF 17,50*
ISBN 978-3-7893-9909-1

Der Tischgebete-Toaster
Mit 50 Gebeten
Nr. 623.507, € 12,95*
€[A] 13,30*/CHF 19,30*
EAN 4250330935077

Ulrich Wendel, Annegret Prause
7 Minuten für mich mit Gott
Das Tagebuch
Nr. 629.862, € 18,–
€[A] 18,60/CHF 27,70*
ISBN 978-3-7893-9862-9

Elena Schulte, Stennie (Illustr.) Ganz. Schön. Lebendig.
In 12 Monaten entdecken, was Gott für dich bereithält
Nr. 629.890, € 23,–
€[A] 23,70/CHF 31,10*
ISBN 978-3-7893-9890-2
Christof Lenzen
Mutig und stark – Kraftvolle Impulse für alle Wochen des Jahres
Nr. 629.841, € 14,95
€[A] 15,40/CHF 20,20*
ISBN 978-3-7893-9841-4

Bibel-Lettering Ideenbuch
Bibelverse, Anleitungen, Sprüche, Projekte
Nr. 629.839, € 14,99
€[A] 15,50/CHF 20,20*
ISBN 978-3-7893-9839-1

Georgia Mix, Holger Mix Kostpaarzeiten
Der Adventskalender für Paare
Nr. 629.864, € 12,99
€[A] 13,40/CHF 17,50*
ISBN 978-3-7893-9864-3
wertvoll – 50 Verheißungen für dich
Nr. 623.493, € 9,95*
€[A] 10,20*/CHF 14,80*
EAN 4250330934933
Blühende Worte –
50 x Ermutigung für dich
Nr. 623.448, € 9,95*
€[A] 10,20*/CHF 14,80*
EAN 4250330934483

Jeannette Mokosch
Dein blühender Alltag
Nr. 629.902, € 20,–
€[A] 20,60/ CHF 27,–*
ISBN 978-3-7893-9902-2
Jeannette Mokosch
Dein blühendes Zuhause
Nr. 629.878, € 19,99
€[A] 20,60/CHF 27,–*
ISBN 978-3-7893-9878-0
Die vollständige Backlist
finden Sie im Händlerportal: haendlerportal.scm-verlagsgruppe.de
Alle Magazine erhalten Sie zum Vorzugseinkaufspreis mit 35 % Buchhandelsrabatt auf den Einzelverkaufspreis.

6 Ausgaben pro Jahr
Einzelverkaufspreis pro Heft:
€ 5,10*/CHF 7,25*

4 Ausgaben pro Jahr
Einzelverkaufspreis pro Heft:
€ 7,60*/CHF 10,90*

6 Ausgaben pro Jahr
Einzelverkaufspreis pro Heft:
€ 6,40*/CHF 9,10*

10 Ausgaben pro Jahr
Einzelverkaufspreis pro Heft:
€ 3,70*/CHF 5,50*

4 Ausgaben pro Jahr
Einzelverkaufspreis:
€ 7,80*/CHF 11,40*

4 Ausgaben pro Jahr
Einzelverkaufspreis pro Heft:
€ 7,70*/CHF 11,–*

6 Ausgaben pro Jahr
Einzelverkaufspreis pro Heft:
€ 5,10*/CHF 7,25*

6 Ausgaben pro Jahr
Einzelverkaufspreis pro Heft:
€ 6,30*/CHF 9,–*

4 Ausgaben pro Jahr
Einzelverkaufspreis pro Heft:
€ 6,10*/CHF 8,70*

4 Ausgaben pro Jahr
Einzelverkaufspreis pro Heft:
€ 9,–*/CHF 12,80*

6 Ausgaben pro Jahr
Einzelverkaufspreis pro Heft:
€ 6,30*/CHF 9,–*

4 Ausgaben pro Jahr
Einzelverkaufspreis pro Heft:
€ 7,10*/CHF 10,10*

Faszination Bibel
4 Ausgaben pro Jahr
Einzelverkaufspreis pro Heft:
€ 7,80*/CHF 13,90*

4 Ausgaben pro Jahr
Einzelverkaufspreis pro Heft:
€ 9,20*/CHF 15,30*

2 Ausgaben pro Jahr
Einzelverkaufspreis pro Heft:
€ 18,90*/CHF 28,40*
Mit den schön gestalteten Geschenk-Gutscheinen können Sie Ihren Kunden jetzt unsere Zeitschriften im Abo anbieten – und damit von den AboUmsätzen eines ganzen Jahres profitieren. Ihre Kunden suchen sich aus dem Display den Gutschein ihrer Wunschzeitschrift aus. Das Abo kann der Beschenkte ganz unkompliziert im Onlineshop oder per Telefon durch einen Code aktivieren.
Keine Investitionskosten.
Verkaufsförderung für Einzelzeitschriften in Ihrer Buchhandlung (als Zusatzgeschenk zum Gutschein).
Umsatz sofort in Ihrer Kasse. Geringe Stellfläche (H 50 / B 12 / T 17,5 cm).
Abrechnung erst nach Einlösen des Gutscheines.
Im Fall des Nicht-Einlösens verbleiben 100 % Erlös im Buchhandel!



2 Ausgaben pro Jahr
Einzelverkaufspreis pro Heft:
€ 19,80*/CHF 28,40*



Gratis Verkaufsmodul.
Hochwertige Geschenkgutscheine (DIN lang) für 12 verschiedene Zeitschriften.
Kostenlose Nachlieferung der verkauften Gutscheine.
Gutscheincodes (getrennt vom Gutschein). Dadurch kein Verlust, wenn Gutschein geklaut wird oder abhandenkommt.







Überraschen Sie mit starken Angeboten in der Adventszeit:
Dieses Jahr gibt es wieder die beliebten Adventskalenderwochen mit tollen Produkten und Preisen für Sie und Ihre Kundschaft. Vom 2.–24.12. stellen wir Ihnen täglich (außer sonntags) reduzierte Produkte zur Verfügung. Zusätzlich erhalten Sie Werbematerialien zum Bekanntmachen der Aktion.
2.–24. Dezember 2024

Plakat A4 »Adventskalenderaktion 2024« Tagesplakate 20er-Set Nr. 950.136.002
Alle wichtigen Daten zur Aktion erhalten Sie von unserem Außendienst oder bei
Friedemann Hruby E-Mail: hruby@scm-verlagsgruppe.de Telefon: 07031 7414-260
Leporello »Adventskalenderaktion 2024« – 25er-Set Nr. 950.136.003























Mit dem »segensreich« bieten wir Ihnen und Ihrer Kundschaft einen spannenden Katalog mit vielen Neuheiten. Toll gestaltet mit redaktionellen Inhalten wie Interviews oder Buchauszügen. Auch im Herbst stellen wir Ihnen





Katalog »segensreich«
den »segensreich« wieder im praktischen DIN-A5-Format zur Verfügung. Dieses eignet sich besonders gut zum Beilegen und Versenden.







DIN A5 2/24 Herbst Handel 50er-Paket
Inhalt: Neuheiten
24 Seiten
DIN A5
Nr. 950.029.224
Erscheint: September 2024

Bei Wunsch eines Firmeneindrucks ab 1.000 Stück wenden Sie sich bitte an Friedemann Hruby: hruby@scm-verlagsgruppe.de
Plakate und Tischaufsteller

Plakat A3
»Comer: Leben vom Meister lernen« Nr. 950.122.002

Plakat A3
»Das hat Gott richtig gut gemacht« Nr. 950.130.001

Plakat A3
»Initiative Schöpfung« Nr. 950.125.002

Plakat A3
»Gute Nacht, Fuchs und Hase« Nr. 950.131.001
Postkarten und Sonstiges

Postkarte DVD-Format »Psalmen – Motiv 1« – 25er-Set Nr. 950.134.001

Postkarte DVD-Format »Psalmen – Motiv 2« – 25er-Set Nr. 940.134.002

Plakat A3
»Flemming: Schonungslose Gnade« Nr. 950.127.001

Plakat A3
»Lichtstrahlen 2025« Nr. 950.132.001


Plakat A3
»Sein Wort –meine Welt« Nr. 950.128.001

Postkarte DVD-Format »Psalmen – Motiv 3« – 25er-Set Nr. 940.134.003

Postkarte »herzstärkend« – 25er-Set Nr. 950.135.001
Plakat A3 »Die 4 vom See: Eine verschollene Erinnerung …« Nr. 950.129.001



Aufkleber Logo
»Initiative Schöpfung« –Bogen mit 48 Stk. Nr. 950.125.003


Visitenkartenkalender »Jahreslosung 2025« – 25er-Set Nr. 950.107.025





Tischaufsteller


»Initiative Schöpfung« Nr. 950.125.004
Lesezeichen »Fokus« – 25er-Set Nr. 950.133.001

Sammelleseprobe
»Initiative Schöpfung« – 25er-Set Nr. 950.125.001

Sammelleseprobe
»Geistliches Leben
Herbst 2024« – 25er-Set Nr. 950.126.001

Bildnachweise
Enthält Leseproben zu diesen Titeln
• Verena Keil / Tobias Hambuch (Hrsg.) – One God. One Planet. One Challenge.
• Matthew Paul Turner – Komm, entdecke Gottes bunte Welt!
• Andy McGuire – Das hat Gott richtig gut gemacht!
• Anja Schäfer – Nachhaltiger leben
• Betsy Painter – Seine wundervolle Welt
• Dörte Heyn – Bäume pflanzen, die in den Himmel wachsen
Enthält Leseproben zu diesen Titeln
• Annalena Pabst – Fokus
• Daniel Grothe – Die Kraft des langsamen Glaubens
• Friedhelm Holthuis – Glaube = Risiko
• Simon Edwards – Ich denke, also glaube ich?
• Fabian Vogt – Mit leuchtenden Augen

Sammelleseprobe
»Biografien Herbst 2024«
– 25er-Set Nr. 950.126.003

Sammelleseprobe
»Romane Herbst 2024«
– 25er-Set Nr. 950.126.002


Einzelleseprobe
»Comer: Leben vom Meister lernen«
– 25er-Set Nr. 950.122.001



Enthält Leseproben zu diesen Titeln
• Mick Fleming – Schonungslose Gnade
• Uwe Heimowski – Mit dem Leben spielt man nicht
• Klaus Heizmann – Mein Leben in Dur und Moll
• Vivien Neufeld – Der Tag, an dem der Sommer zu Ende ging
Enthält Leseproben zu diesen Titeln
• Cathy Gohlke – In Zeiten der Freundschaft
• Eline Rosenhart – Mein Land, mein Leben
• Iris Muhl – Ein Lied für den Fein
• Dorothea Morgenroth –Das Versprechen eines neuen Tages
• Brigitte Liebelt – Die Vikarin
• Elisabeth Büchle – Rebellin mit Herz
Einzelleseprobe
»Ramsden: Herzen ohne Mauer«
– 25er-Set Nr. 950.123.001
Binder, Sandra: Fany Fazii (www.fotografinnen.de) | Bleier, Bianka: Nakischa Scheibe | Comer, John Mark: Rob Campbell Photography / Ameris Photography Inc. | Eckstein, Hans-Joachim: Eckstein Production Holger Eckstein | Edwards, Simon: 2021 Simon Edwards | Fleming, Mick: Church on the Street | Gisin, Walter: privat | Gohlke, Cathy Tyndale House Publishers Inc. | Grothe, Daniel: Ashlee Weaver | Halbmeyer, Tabea: Picture People | Heyn, Dörte: Dörte Heyn | Heimowski, Uwe: Moser Fotografie & Postproduktion | Heizmann, Klaus: Paul Yates | Herzen ohne Mauer (Titelbild): bpk / Bundesstiftung Aufarbeitung / Jürgen Nagel | Herzstärkend: La Rici Photography (www.lariciphotography.com) | Holthuis, Friedhelm: Marian Stegk; Credo Church | Jope, Rüdiger: Rüdiger Jope | Lennox, John: John Lennox | Liebmann, Tobias: CVJM Westbund | Lombardi, Alexander: Alexander Lombardi | McGuire, Andy: Zondervan / HarperCollins Christian Publishing | Muhl, Iris: Sabina-Bösch | Müller, Ingo: Ingo Müller | Neufeld, Vivien: Sebastian Heim | Pailer, Norbert: Norbert Pailer | Painter, Betsy: Harper Collins Christian Publishing Inc. | Prause, Annegret: Wolfgang deVries | PreanBruni, Maria: privat | Raedel, Christoph: Olaf Johannson | Ramsden, Viola: Richard Ramsden | Jürgen Nagel | Richter, Thomas: Nill BSK | Rosenhart, Eline: Eline Rosenhart | Schaefer, Anja: Matthias Endlich www.endlichbilder.de | Scherer, Sabina: Ramona Fischer | Schneider, Ira: Diana Frohmüller Photography (www.dianafrohmueller.com) | Schott, Martin: privat | Schünemann, Petra: Petra Schünemann | Schüßler, Alexandra: Matthias Schüßler | Stadelmann, Helge: Stephan Sieber Picturebaer | Stennie: Marina Schell | Stutz, Saraj: Jan Stoller (www.janstoller.ch) | Tempelmann, Inge: 2024 Alice Schwendich | Tölgyesi, Miriam: Miriam Tölgyesi | Tribelhorn, B. Thomas: unbekannt | Ullrich, Ruben: Sylvia Bechle | Vogt, Fabian: Pietro Stutera | Wendel, Kerstin: Deborah Pulverich LYDIA | Wiediger, Sabine: Claudia Kübler | Wortdesign Studio: Maggy Melzer
KONFESSIONELLER BUCHHANDEL

Verlagsvertreter und Christliche Key-Accounts PLZ 2–6
Jörg Viehmann
Gerth Medien
Berliner Ring 62 35576 Wetzlar
Telefon: 06441 20405 935 Mobil: 01577 17 55 190 viehmann@scm-verlagsgruppe.de
Verlagsvertreter Ost PLZ 0, 1, 36–39, 9
Klaus Becker
Lange Straße 70 70794 Filderstadt
Telefon: 07158 69938
Mobil: 0177 26 81 004 becker@scm-verlagsgruppe.de
Verlagsvertreter Süd PLZ 7, 8
Martin Steiert
Ludwig-Dürr-Straße 36 73033 Göppingen
Telefon: 07161 71 233
Mobil: 0177 26 81 002 steiert@scm-verlagsgruppe.de
SCHWEIZ



Auslieferung Schweiz



Fontis AG
Steinentorstrasse 23 CH-4051 Basel
Telefon: +41 (0) 61 295 60 01 auslieferung@fontis.ch www.fontis-shop.ch
Verkaufsleitung Schweiz
Roland Sigrist
Telefon: +41 (0) 61 295 60 95 r.sigrist@fontis.ch
Verkauf Schweiz
Brigitte Bégert
Telefon: +41 (0) 61 295 60 01 b.begert@fontis.ch
Co-Auslieferung im allgemeinen Buchhandel
Buchzentrum AG
Industriestrasse Ost 10 4614 Hägendorf
Telefon: +41 (0) 62 209 26 26 kundendienst@buchzentrum.ch


IHRE SCM-ANSPRECHPARTNER

Vertrieb Handel Innendienst und Key-Account
Andrea Volland
Berliner Ring 62 35576 Wetzlar
Telefon: 06441 204 05 717 volland@scm-verlagsgruppe.de

Vertrieb Handel, Teamleitung Innendienst
Friedemann Hruby
Max-Eyth-Straße 41 71088 Holzgerlingen
Telefon: 07031 7414-261 hruby@scm-verlagsgruppe.de


Leitung Key-Accounts Hans-Günter Moß Max-Eyth-Straße 41 71088 Holzgerlingen
Telefon: 07031 7414-355 moss@scm-verlagsgruppe.de



Zusätzlich reist für Sie im allgemeinen Markt: Grenners Verlagsvertretungen Riedweidenstr. 2 79331 Teningen
Sabine Grenner und Cornelius van Vugt
Telefon: 07641 958 611 Telefax: 07641 958 622 service@grennersverlagsvertretungen.de




Presse- und Öffentlichkeitsarbeit
Jürgen Asshoff Bodenborn 43 58452 Witten
Telefon: 02302 930-93-781 asshoff@scm-verlag.de





Presse- und Öffentlichkeitsarbeit Musik
Patrick Jakucs
Max-Eyth-Straße 41 71088 Holzgerlingen
Telefon: 07031 7414-282 jakucs@scm-verlag.de


Bremen
Bremen
Hannover
Hannover
Magdeburg
Witten
Düsseldorf
Düsseldorf Witten
Erfurt
Wetzlar
Wetzlar
Wiesbaden
Wiesbaden
Nürnberg
Saarbrücken
Saarbrücken
1 2 3 4 5
Stuttgart Holzgerlingen
Stuttgart Holzgerlingen
München
Innsbruck

Verlagsvertretungen Österreich Claudia Lambourne Kriftmaurerweg 1 4490 St. Florian +43 (0) 699 11594172 lambourne@buchdealer.at www.buchdealer.at

Auslieferung und Service durch die verlagseigene Auslieferung der SCM Verlagsgruppe
SCM Verlagsgruppe GmbH Max-Eyth-Straße 41 71088 Holzgerlingen
Telefon: 07031 7414-188
Telefax: 07031 309 9605-119
E-Mail: bestellen-handel@scm-verlagsgruppe.de haendlerportal.scm-verlagsgruppe.de
Alle Angaben: Stand April 2024 | Irrtum und Preisänderungen vorbehalten | Werbemittelabbildungen vorläufig Alle Barcodes auf Basis der ISBN | Nr. 950.005.224 | * unverbindl. Preisempfehlung
»Die Initiative Schöpfung bringt im großen Stil eines unserer Herzensthemen ins Gespräch. Da sind wir natürlich mit dabei!«
TABEA GUTMANN, Micha Deutschland e. V.
»Wandel braucht Mut. Und Mut braucht Gemeinschaft. Dafür steht für mich die Initiative Schöpfung.«
ANNE PAPPERT, Evangelische Kirche in Deutschland
»Die Welt ist ein Geschenk des Himmels: Wer an Gott als Schöpfer und Retter der Welt glaubt, nimmt Verantwortung für diese Welt wahr. Das heißt auch: Einfache Antworten genügen nicht. Es braucht immer wieder neue Initiativen, die Glauben und Leben in Gottes guter Schöpfung zusammenbringen.«
STEFFEN KERN, Gnadauer Verband